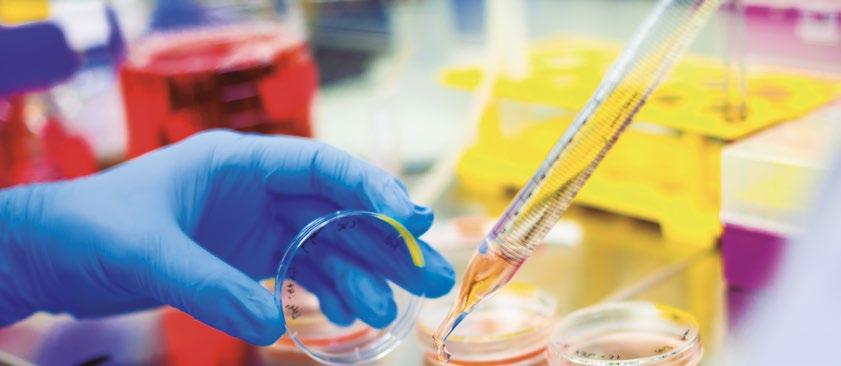
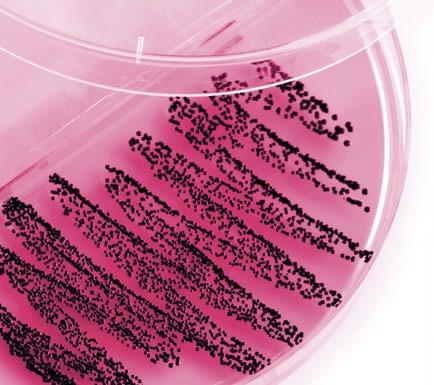
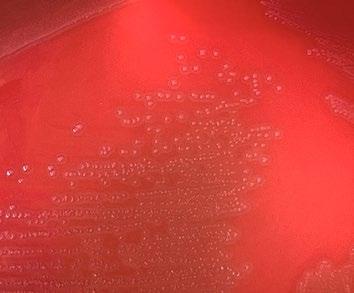
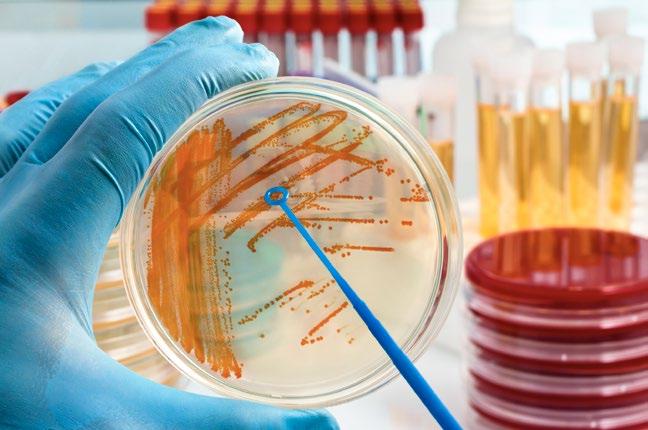

TOMA DE MUESTRAS





AVANZAR CON PROPÓSITO: CIENCIA, BIENESTAR Y FUTURO COMPARTIDO
El sector porcino no se detiene. Evoluciona, se cuestiona, incorpora nuevos métodos y revisa los antiguos.
No se trata solo de aplicar protocolos o perfeccionar rutinas, sino de entender que cada mejora contribuye a un sistema cada vez más sólido y preparado para los retos del presente.
Trabajar en producción porcina implica convivir con un entorno sanitario dinámico, donde las decisiones deben tomarse con criterio y precisión. Desde cómo se conserva una vacuna hasta la forma en la que se organiza un muestreo, pasando por la interpretación de datos o el seguimiento de un lote, cada paso tiene impacto.
La atención constante a la calidad del trabajo técnico es una de las señas de identidad del sector.
No es casualidad que hoy se hable con tanta naturalidad de vigilancia, bioseguridad, formación o diagnóstico temprano: forman parte del lenguaje común porque forman parte de la responsabilidad diaria.
Al mismo tiempo, muchas explotaciones están viviendo un cambio generacional que trae consigo nuevas competencias, nuevas maneras de comunicar y una visión más amplia del papel del sector en la sociedad.
Jóvenes que regresan al entorno rural con formación, que entienden la tecnificación como una oportunidad y que reivindican con orgullo una actividad que genera riqueza, empleo y estabilidad en el territorio.
Su presencia no solo asegura relevo, refuerza la idea de que producir alimentos es una tarea noble, compleja y profundamente necesaria.
En ese camino compartido destaca un desafío central: la lucha contra las resistencias antimicrobianas.
Es un reto que no admite enfoques aislados. Requiere coordinación entre veterinarios, ganaderos, empresas, integradoras y laboratorios. Exige revisar prácticas, optimizar procesos y apostar por la prevención como primera herramienta de control. Avanzar en este ámbito no es solo proteger la eficacia de los tratamientos, sino consolidar un modelo productivo más robusto y sostenible.
La sostenibilidad económica, social y medioambiental completa este enfoque global.
La gestión eficiente de recursos, la reducción de emisiones, el uso de energías renovables o la digitalización no son tendencias pasajeras, sino herramientas que permiten producir con mayor responsabilidad y resiliencia. Son decisiones que fortalecen la imagen del sector y que demuestran, con hechos, que la innovación también forma parte del ADN porcino.
En conjunto, este número refleja un sector que avanza con propósito. Que observa, que adapta, que innova y que comparte una visión común: producir de forma responsable, sostenible y alineada con las demandas técnicas y sociales de nuestro tiempo. Un sector que sabe que el futuro no se improvisa, sino que se construye cada día, con rigor, con compromiso y —sobre todo— trabajando juntos.
EDITOR
GRUPO DE COMUNICACIÓN
AGRINEWS S.L.
PUBLICIDAD
Laura Muñoz
+34 629 42 25 52
Luis Carrasco
+34 605 09 05 13
REDACCIÓN
Daniela Morales Óscar Cáceres
COLABORADORES
Alberto Morillo Alujas
Laura Pérez
Jordi Baliellas
Vicens Enrique-Tarancón
Fernando Laguna
ADMINISTRACIÓN
Mercè Soler
Barcelona
España
Tel: +34 93 115 44 15 info@agrinews.es www.porcinews.com
Precio de suscripción anual: España 30€ Extranjero 90€
DIRIGIDA A VETERINARIOS DE PORCINO
Depósito Legal Porcinews B17989-2015
ISSN (Revista impresa) 2696-8029
ISSN (Revista digital) 2696-8037
Revista Trimestral
La dirección de la revista no se hace responsable de las opiniones de los autores. Todos los derechos reservados.

CONTENIDOS
4/19
Bioseguridad porcina 360°: de las barreras visibles a los reservorios ocultos - Parte II

David García Páez
Especialista en Bioseguridad
Aplicada en OneSilex
Esta segunda parte aborda puntos críticos menos visibles de la bioseguridad porcina, como silos, biofilms o fosas de purines.
20/26
Pulse. Administración sin aguja para porcino: dosis precisas, rapidez y bioseguridad
Servicio Técnico de Datamars Livestock
28/37
Toma de muestras a nivel de campo: el primer eslabón para alcanzar un buen diagnóstico laboratorial


Gema Chacón y Mireya Melero
Exopol S.L.
Una toma de muestras adecuada en granja es clave para lograr un diagnóstico laboratorial fiable y orientar con precisión el tratamiento o las medidas preventivas.
38/40
“Juntos lo hacemos posible”: la iniciativa de Boehringer Ingelheim para respaldar a los profesionales ante los nuevos desafíos de la industria
Servicio Técnico de Boehringer Ingelheim Animal Health
42/48
Vigilancia de resistencias en bacterias patógenas clínicas: herramienta clave para la prescripción responsable de antibióticos en veterinaria


Cristiana Teixeira Justo1, Cristina Muñoz2 y María J. Vilar1

1Técnico científico del PRAN en Sanidad Animal
2Coordinadora del PRAN en Sanidad Animal
El Mapa Epidemiológico del PRAN permite ajustar la prescripción antibiótica en veterinaria a partir de datos de resistencia en bacterias patógenas clínicas.
50/56
Claves para un manejo óptimo del proceso de vacunación en lechones
Fernando Cerro
Servicio Técnico de Ceva Salud Animal
58/62
Síndrome de dermatitis ulcerativa en cerdas: ¿Te suena?

Paula Sánchez Giménez Técnico Veterinario CEFU S.A.
Desorden crónico, lesiones llamativas y muchos interrogantes: así se manifiesta el síndrome de dermatitis ulcerativa porcina.
Agradecemos a nuestros anunciantes por hacer posible la publicación de esta revista: Arvet Veterinaria, Bbzix, Bioplagen, Boehringer Ingelheim Animal Health, Ceva Salud Animal, Datamars Livestock, Grupo Innofarm, Inserbo, Interporc, Lidervet, Liptosa, Nediver-Axiom, New Farms, Quimicamp y Vetia Animal Health.

FINTOX PRO ADVANCE UE
Secuestrante de micotoxinas con ingredientes cuidadosamente seleccionados:
Silicatos y aluminosilicatos
Paredes celulares y productos de fermentación microbiana
Provitaminas
FOS + MOS
Componentes vegetales
Harina de algas

Válido para piensos de aves de corral, cerdos y rumiantes

com
com

BIOSEGURIDAD PORCINA 360° DE LAS BARRERAS VISIBLES A LOS RESERVORIOS OCULTOS - PARTE II
David García Páez
Especialista en Bioseguridad Aplicada en OneSilex

Tras revisar en la primera parte los fundamentos de la bioseguridad porcina, desde las barreras visibles y estructurales hasta la organización del manejo diario, nos adentramos ahora en una dimensión más silenciosa pero igualmente decisiva: los reservorios ocultos.
En esta segunda parte analizaremos cómo líneas de pienso, tuberías, silos, rincones húmedos y plagas pueden convertirse en aliados invisibles de bacterias, virus y hongos, y qué estrategias permiten neutralizarlos para blindar verdaderamente la granja.

LA BIOSEGURIDAD OCULTA: LA
TRASTIENDA DEL PROBLEMA
Más allá de los protocolos generales de bioseguridad y las barreras visibles, el verdadero éxito de la bioseguridad reside en la atención al detalle y en la capacidad de identificar y neutralizar los “puntos ciegos” o puntos críticos.
Existen zonas que, por ser de difícil acceso para el personal, para y por la limpieza y/o la desinfección, se convierten en reservorios ideales para patógenos, perpetuándose a corto, medio y largo plazo en ciclos de reinfección, mermando la productividad de forma silenciosa y continuada.
Veamos algunos ejemplos prácticos:
¿Qué consecuencias tiene esto?
Las implicaciones son graves, entre ellas:
Consumo irregular de pienso debido a la alteración de su palatabilidad y calidad nutricional.
BUENAS PRÁCTICAS
LÍNEAS DE ALIMENTACIÓN: LA AUTOPISTA DE SALMONELLA SPP.
El pienso viaja veloz por las líneas de alimentación, pero deja detritus, migajas, polvo graso que, junto a la humedad, ya sea, de la explotación o bien tras una limpieza a fondo con la penetración de esta en el interior de las líneas, se vuelve un cemento orgánico, una costra adherida a las paredes internas de las líneas.
Allí se acantonan y proliferan patógenos como Salmonella spp., Clostridium spp., así como hongos productores de micotoxinas.
Estos microorganismos y sus toxinas son luego arrastrados por el pienso fresco, colonizando tolvas y, finalmente, el intestino de los animales, generando un ciclo de reinfección constante y recidivante
Diarreas y blandeos persistentes que afectan el crecimiento y la uniformidad de los lotes.
Problemas sanitarios crónicos derivados de la exposición continua a micotoxinas, que merman la ganancia diaria de peso y la eficiencia alimenticia.


La limpieza de las líneas de alimentación debe ser una prioridad, no un “ya veremos si hay problemas…”.
Es fundamental vaciar por completo las líneas entre cada lote, asegurando que no queden restos de pienso concentrado.

Una vez que estén limpias de restos, se recomienda la aplicación de productos específicos para la limpieza en seco, con el objetivo de arrastrar residuos y ayudando a desincrustar los restos adheridos sin añadir humedad para evitar así nuevamente el crecimiento exacerbado de microorganismos.

Una desinfección por vía aérea puede ser útil para reducir la carga microbiana residual que hayamos podido poner por vía aerógena debido a los fómites y otras partículas en suspensión.
SILOS: TORRES CON SECRETOS
Por dentro, el silo es un mundo aparte, una torre con secretos que a menudo guardan problemas.
Piensen en esas madrugadas frías, cuando la condensación se adhiere a las paredes internas, creando apelmazamientos en la boca del cono y, lo que es peor, fermentaciones silenciosas de pienso que nadie ve.
Estos apelmazamientos y la humedad son el caldo de cultivo ideal para levaduras, mohos y bacterias, que no solo degradan la calidad nutricional del pienso, sino que también producen micotoxinas.
¿Qué consecuencias tiene esto?
La contaminación del pienso nuevo es inevitable, lo que lleva a una reducción de su calidad y palatabilidad. Esto se traduce en:
Una menor ingesta por parte de los animales.
Bloqueos en el flujo de alimento hacia los sinfines.
La formación de toxinas que aumentan el recuento de hígados decomisados en matadero y afectan la salud general de la piara.

La retirada del pienso sobrante entre lotes, así como la limpieza interna en seco entre cada llenado es clave e indispensable. Esto implica vaciar completamente el silo y, si es posible, realizar una limpieza manual o con equipos de aspiración para eliminar cualquier residuo adherido.

La inspección endoscópica trimestral permite detectar acumulaciones problemáticas y evaluar la eficacia de la limpieza, no solo en el cono del silo sino también en la transversal que une la base de este con las tolvas de alimentación.


desinfección por atomización seca con productos biodegradables, no tóxicos ni carcinogénicos y que puedan emplear cualquier granjero u operario dentro de la explotación es un magnífico recurso tras la limpieza con productos específicos en seco para superficies secas y que pueden complementar esta, reduciendo la carga microbiana, así como aquellos acantonamientos que pudieran darse en su interior, por muy recónditos que puedan estar.
LÍNEAS DE AGUA: UN RÍO
CUBIERTO POR BIOFILM
El agua es el alimento, nutriente, complemento más importante y, a menudo, más olvidado en las explotaciones porcinas.
El biofilm, una comunidad de microorganismos (bacterias, algas, hongos) adherida a las superficies internas de las tuberías, es un problema altamente persistente y muy astuto.

¿Qué consecuencias tiene esto?
La presencia de biofilm se traduce en una fuente constante de reinfección para los animales, fracaso de tratamientos orales que no alcanzan la dosis mínima eficaz y rehidrataciones fallidas, especialmente críticas en lechones jóvenes o estresados.
Crea una película mucosa que protege a patógenos como E. coli, Salmonella spp. o Mycoplasma, y lo que es aún más preocupante, puede inactivar o reducir la eficacia de medicamentos, ya sean antibióticos, sales, ácidos orgánicos o vacunas, administrados a través del agua de bebida, haciendo que los tratamientos sean ineficaces y en muchos casos inútiles.
¡El lechón supuestamente recibe la medicación, pero es el biofilm el que se la queda!

El biofilm puede causar obstrucciones en los chupetes y las líneas, tanto en las aéreas como en las verticales, reduciendo el acceso al agua y afectando el rendimiento productivo.
BUENAS PRÁCTICAS

La implementación de programas periódicos de flushing de las líneas de agua es crítica y debe ser una rutina inquebrantable.
Esto incluye el uso de peróxidos estabilizados o ácidos, sean inorgánicos u orgánicos siempre y cuando se administren de forma controlada y medida, y que ayudarán a disolver el biofilm y, por tanto, a eliminar los microorganismos.


Las purgas de agua en los finales de línea, en las transversales o aéreas son esenciales para arrastrar los residuos desprendidos y asegurar que el agua fresca y limpia llegue a todos los bebederos.
Un diseño hidráulico adecuado que evite estancamientos y asegure una velocidad mínima de flujo (idealmente 0,3 m/s) es crucial para prevenir la formación de biofilm.
Usar productos para la limpieza y el flushing de las líneas de agua en presencia de animales haciendo que estos restos sean consumidos por los mismos, sin duda alguna, no tiene una justificación racional.
FOSAS DE PURINES: EL DRAGÓN BAJO EL SUELO

Aunque estén bajo las instalaciones, las fosas de purines son una fuente masiva de amoníaco y aerosoles cargados de patógenos
Bajo el slat, la mezcla de estiércol y orina genera amoníaco y calor que, unido a la humedad, crean un ambiente propicio para la proliferación y el crecimiento microbiano.
Si la fosa no se vacía a tiempo o no se maneja de forma adecuada, la columna de aire se carga de aerosoles microbianos, fómites y gases nocivos que ascienden a las naves, afectando directamente a la calidad del aire que respiran los animales y el propio personal de la explotación.
¿Qué consecuencias tiene esto?
Las implicaciones para la salud animal y humana son directas y significativas:
Tos crónica en cebo.
Problemas respiratorios severos (bronquitis, neumonías).
Riesgo de enfermedades como PRRS o leptospirosis.
En el personal, infecciones oculares, irritación de las vías respiratorias y otros problemas de salud ocupacional.
La alta concentración de amoníaco afecta el bienestar animal, reduce el consumo de pienso y puede mermar el rendimiento productivo.
BUENAS PRÁCTICAS

La evacuación completa de las fosas entre lotes es una medida indispensable para romper el ciclo de patógenos y reducir la emisión de gases.


El uso de productos específicos como los digestores de purines que ayuden a licuar y fijar el amoniaco además de facilitar el vaciado y reducir la emisión de gases es muy útil como herramienta.

Tras el vaciado, un lavado a presión exhaustivo de las paredes y el suelo de la fosa ayuda a eliminar los residuos adheridos y los biofilms.

El diseño del drenaje que asegure la evacuación total del purín y evite zonas muertas es fundamental.
SISTEMAS DE PAD-COOLINGS: EL PULMÓN HÚMEDO
Los sistemas de pad-coolings son esenciales para el confort térmico de los animales en verano, especialmente en climas cálidos, pero si no se mantienen adecuadamente, se convierten en un foco de problemas teniendo en cuenta la cantidad de litros de aire que por ellos salen para enfriar las naves.
Estos pueden acumular materia orgánica, polvo y humedad, creando un ambiente ideal para el crecimiento de algas, bacterias y hongos como Aspergillus, que pueden ser patógenos respiratorios. Además, se dan casos de acantonamientos de Salmonella spp. debido a las incrustaciones calcáreas que se dan entre el material de celulosa que genera por capilaridad el enfriamiento del aire que por ellos pasan.
¿Qué consecuencias tiene esto?
La proliferación de estos microorganismos se traduce en:
Problemas respiratorios en animales y operarios (rinitis, neumonías, aspergilosis, colibacilosis, salmonelas, etc.).
Reducción significativa de la eficiencia del sistema de enfriamiento, lo que se refleja en un mayor consumo energético (hasta un 18 % más) para mantener la temperatura deseada, con un aumento del consumo de oxígeno por parte de los animales.
Si las fosas están muy llenas de purín, la liberación de amoniaco puede desplazar el oxígeno existente, por lo que entramos en un bucle de difícil solución para la nave en concreto.
BUENAS PRÁCTICAS

Es crucial realizar una limpieza química periódica con productos específicos, como espumas ácidas, que disuelvan las incrustaciones y eliminen los microorganismos, así como las superficies que pueden generar su acantonamiento.

El desmontaje parcial de los paneles para una limpieza a fondo es una práctica recomendada, permitiéndose así una desinfección más exhaustiva.

Un secado forzado de los paneles durante al menos 48 horas antes de su uso en la campaña estival es vital para evitar la proliferación de patógenos.
PASAR DEL “PARECE LIMPIO” AL “ESTÁ COMPROBADO”
A veces, la vista engaña. Una pared puede brillar y, sin embargo, ocultar 10.000 RLU de ATP, ADP y AMP.
Es por ello por lo que la inspección visual, aunque necesaria, no es suficiente para garantizar que una superficie está realmente limpia a nivel microbiológico.
Para superar estas limitaciones y transformar la bioseguridad de un arte basado en la percepción a una ciencia basada en datos, la tecnología de bioluminiscencia con medición en niveles de RLU de ATP, ADP y AMP se ha consolidado como una herramienta de validación rápida y objetiva, indispensable en la bioseguridad actual.

Este método no detecta un patógeno específico, sino el trifosfato, difosfato o monofosfato de adenosina (ATP, ADP o AMP), la molécula de energía presente en todas las células vivas (bacterianas, fúngicas, vegetales, animales).
La detección de una alta cantidad de ATP, ADP o AMP indicaría la presencia de materia orgánica residual, el sustrato perfecto para la supervivencia y multiplicación de patógenos.
Las tecnologías más avanzadas como las del Lumitester Smart®, de Kikkoman y sus hisopos Surface A3 mide no solo ATP, sino también ADP y AMP, las formas degradadas del ATP, ofreciendo una imagen aún más rigurosa y fiable de la concentración de carga microbiológica total, así como de la eficacia de la limpieza, antes y después, así como de la desinfección posterior.

TRATAMIENTO DE AGUA

MEJORA LA CALIDAD MICROBIOLÓGICA DEL AGUA
ELIMINA EL BIOFILM
ELIMINA DEPÓSITOS DE CAL

· Eficacia probada por normas UNE oficiales europeas.
· 100% Estable.
· 100% Biodegradable.
¿Cómo funciona?
El proceso es sencillo, rápido y puede ser realizado por el propio personal de la granja tras una breve formación:
1


Toma de muestra: se frota una superficie con un hisopo específico, diseñado para recoger eficientemente las muestras de ATP, ADP Y AMP.

3
Emisión de luz: la luciferasa reacciona con el ATP/ADP/AMP presente en la muestra, emitiendo una luz (bioluminiscencia) cuya intensidad es directamente proporcional a la cantidad de carga microbiana viva sobre la superficie muestreada.

2
Reacción química: el hisopo se introduce en un reactivo que contiene la enzima luciferasa, la misma que hace brillar a las luciérnagas.

4
Cuantificación: un luminómetro (Lumitester Smart) mide esta luz y la cuantifica en Unidades Relativas de Luz (RLU), proporcionando un valor numérico objetivo y reproducible para cada punto crítico o ciego.
Las ventajas de esta tecnología son innegables y la convierten en una herramienta invaluable para la gestión de la bioseguridad: BUENAS PRÁCTICAS
Los resultados se obtienen en menos de 30 segundos, permitiendo una toma de decisiones inmediata y la corrección de deficiencias en tiempo real.

Proporciona un valor numérico comparable con umbrales preestablecidos, eliminando la subjetividad de la inspección visual y las conjeturas del personal.
Rapidez Objetividad

Permite tomar medidas correctoras de forma inmediata si un punto no cumple los estándares de limpieza, evitando la diseminación de patógenos y la aparición de brotes.
Proactividad


Es una excelente herramienta para formar al personal, demostrando visualmente la importancia de una limpieza bien hecha y el impacto directo de su trabajo en la salud animal y la rentabilidad de la granja.
Formación y concienciación
Su aplicación en los puntos críticos mencionados (paredes de silos, bebederos, conductos de aire, superficies de equipos, suelos, paredes) permite mapear la granja: un código de colores sobre plano revela puntos calientes que insisten en fallar, permitiendo focalizar los esfuerzos de limpieza.
El resultado numérico es evaluador per se: el operario ve el número, entiende la deficiencia y, sobre todo, celebra el verde como un gol en el último minuto del partido, fomentando una cultura de mejora continua y responsabilidad compartida.
Umbrales de alerta: es fundamental establecer umbrales claros y adaptados a cada granja y/o integradora y a su sistema de calidad, así como al tipo de superficie.
A modo de ejemplo, podríamos considerar:

Rojo: >8.000 RLU – ¡Repetir limpieza ya!
Indica una limpieza deficiente y un alto riesgo de contaminación, requiriendo una intervención inmediata.

Amarillo: 1.000-8.000 RLU – ¡Repasar puntualmente!
Sugiere que la limpieza es aceptable, pero puede mejorarse en puntos específicos, indicando áreas de oportunidad.

Verde: <1.000 RLU – ¡Seguimos!
Confirma una limpieza eficaz y un riesgo de contaminación aceptable, aunque no inviable, validando el protocolo aplicado.
EL FACTOR HUMANO: DE SOLDADO A ESTRATEGA
La tecnología no sustituye la actitud y un plan de bioseguridad, por muy bien diseñado y tecnológicamente avanzado que esté, fracasará si no cuenta con el compromiso y la formación del equipo humano.
El personal no solo implementa las medidas, sino que es un potencial vector de transmisión si no está debidamente concienciado y capacitado.
Por ello, es imprescindible invertir en el factor humano, transformando a cada “soldado” que sigue instrucciones en un “estratega” que comprende y se apropia de la bioseguridad.
FORMACIÓN CONTINUA Y CONTINUADA: EL “POR QUÉ” DETRÁS DEL “QUÉ”
Explicar el “por qué” de cada medida es crucial para fomentar la implicación.
Talleres donde se mide por bioluminiscencia en botas antes y después de la ducha enseñan más que cien diapositivas teóricas.
La formación debe ser práctica, interactiva y adaptada a las necesidades y el nivel de comprensión de cada operario, utilizando ejemplos concretos de la granja y si es posible, en la misma explotación, con sus propios recursos.
Demostrar el impacto directo de sus acciones en la salud animal, la reducción de enfermedades y la rentabilidad de la granja fomenta una mayor implicación y responsabilidad

PROTOCOLOS CLAROS Y VIABLES: LA EFICACIA EN LA RUTINA
Las normas deben ser fáciles de entender y aplicar en la rutina diaria.
Un paso extra que añade treinta minutos diarios es viable; cinco pasos nuevos que duplican la jornada, no. Los protocolos deben ser realistas, concisos y estar disponibles en formatos accesibles (carteles, infografías, señalética, videos cortos, etc.) en los puntos clave de la granja.
Es mejor tener pocos protocolos bien aplicados que muchos e ignorados.

bioseguridad
CULTURA DE RESPONSABILIDAD
Y ORGULLO: EL MOTOR DE LA MEJORA CONTINUA
Fomentar que cada miembro del equipo se sienta una pieza clave en la protección sanitaria de la granja.
Celebrar públicamente el lote sin neumonías o la sala que marcó 500 RLU crea pertenencia, refuerza el comportamiento deseado y genera un sentido de logro colectivo.
Cuando el operario ve menos bajas, menos tratamientos y aprecia que los antibióticos se reducen exponencialmente, el protocolo deja de ser una orden para convertirse en una convicción y propuesta de mejora personal.

RETORNO DE INVERSIÓN: NÚMEROS QUE HABLAN
La bioseguridad no es un gasto, sino una inversión estratégica con un retorno tangible y medible.

Los beneficios van mucho más allá de la mera prevención de enfermedades, impactando directamente
Una granja de 3.000 plazas de cebo con una reducción de 0,05 en el Índice de Conversión (IC) gracias a la disminución de micotoxinas y patógenos supone ahorrar 120TM de pienso al año. A un precio estimado de 380€/ TM, hablamos de 45.600€ que no se vuelan en polvo por las tolvas. Si a esto le descontamos 9.000€ anuales en detergentes, luminómetro y formación al personal, el beneficio neto asciende a aproximadamente 36.600€.
Y eso sin contar la caída de mortalidad (cada animal que sobrevive es un ingreso directo), la reducción en el uso de antibióticos (con el consiguiente ahorro y mejora de la imagen), los decomisos evitados en matadero (que impactan directamente en la calidad de la canal), la mejora en el bienestar animal (que se traduce en mayor productividad) y la reputación de la granja (un activo intangible, pero de gran valor comercial).
La inversión en bioseguridad se traduce en una cascada de beneficios:
Mejora de la salud animal: menos enfermedades, menor mortalidad y morbilidad, lo que se traduce en animales más sanos y productivos.
Reducción del uso de medicamentos: disminución de los costes veterinarios y una contribución activa a la lucha contra las resistencias antimicrobianas, un desafío global de salud pública.











Optimización del rendimiento productivo: mejora del índice de conversión, mayor ganancia media diaria, reducción de los días a matadero y mayor uniformidad de los lotes, lo que optimiza la planificación y el flujo de producción.
Mayor rentabilidad: aumento de los márgenes económicos por animal y por ciclo productivo, haciendo la explotación más competitiva.
Mejora de la imagen y reputación: una granja con alta bioseguridad es sinónimo de calidad, responsabilidad y sostenibilidad, lo que puede abrir nuevas oportunidades de mercado y fortalecer la relación con los consumidores y la cadena de valor.
Sostenibilidad: contribución a una producción más eficiente, respetuosa con el medio ambiente y socialmente responsable, aspectos cada vez más valorados por la

CONCLUSIÓN: LA LIMPIEZA QUE SE VE Y LA QUE SE SIENTE
Bioseguridad es, ante todo, una decisión diaria, una filosofía que debe impregnar cada rincón y cada acción en la granja.
Podemos conformarnos con el acero inoxidable reluciente de los boxes, corrales o líneas de agua o, por el contrario, bajar la mirada a las tuberías, a esa sombra rebelde bajo el slat, a esos puntos ciegos que, si no se controlan, se convierten en el talón de Aquiles de nuestra producción.
La bioseguridad moderna exige una visión integral, una atención meticulosa a lo visible y, sobre todo, a lo oculto, a esos detalles que marcan la verdadera diferencia entre una granja que sobrevive y una que prospera.
La tecnología actual, como la monitorización por bioluminiscencia, nos permite no solo mejorar los procesos de limpieza, sino también medir su eficacia en tiempo real, transformando la intuición en datos objetivos y permitiendo una gestión proactiva.
Cada luminómetro que brilla en verde devuelve confianza, tiempo y, al final, euros contantes que llegan a la última línea del balance. En un mundo donde la transparencia alimentaria ha dejado de ser una opción para convertirse en una exigencia, esta inversión no solo nos permite sobrevivir: nos posiciona para liderar, consolidando nuestra reputación y abriendo nuevas puertas comerciales.
Una granja que huele a limpio y muestra datos objetivos de control se vuelve el mejor argumento de ventas ante cualquier cliente exigente, un sello de calidad que trasciende las fronteras de la propia explotación y genera valor a lo largo de toda la cadena de suministro.
Invertir en una limpieza y desinfección profunda y validada, incluso en las zonas más difíciles, no es un coste, sino una garantía de salud, rentabilidad y sostenibilidad a largo plazo para la explotación porcina.
Bioseguridad porcina 360°: de las barreras visibles a los reservorios ocultos - Parte II
ADMINISTRACIÓN SIN AGUJA
PULSE PARA PORCINO:
DOSIS PRECISAS, RAPIDEZ Y BIOSEGURIDAD

En una granja porcina moderna, cada segundo y cada mililitro cuentan.

Entre vacunaciones, tratamientos y procesados, la aguja tradicional se ha quedado corta para lo que exige el negocio: velocidad, consistencia y bioseguridad.

Aquí entra PULSE, la gama de inyectores sin aguja diseñada para liberar la dosis correcta en el plano tisular adecuado (intradérmico, subcutáneo o intramuscular) en menos de 200 milisegundos, con una microapertura cutánea que reduce el trauma, los errores y los riesgos para el equipo.
El resultado es:
Un manejo más rápido, seguro y fiable.
Una mejor respuesta inmunitaria.

Menos incidencias para animales y personas.
Peligro
Las agujas se rompen, pinchan al personal y suponen un riesgo de cuerpos extraños en canal.
PULSE incorpora seguros mecánicos y una ergonomía diseñada para el trabajo intensivo, reduciendo accidentes, estrés y fatiga del equipo.
Menos lesiones suponen menos bajas laborales, menos interrupciones en el ritmo de trabajo y más continuidad en la operación.
¿POR QUÉ “SIN AGUJA”?
Enfermedad
Reutilizar agujas entre animales puede transmitir patógenos.
PULSE elimina la aguja: genera una microapertura en la piel y propulsa el fármaco a alta velocidad hasta la profundidad adecuada.
Al evitar esa vía de transmisión, refuerza la bioseguridad y reduce los riesgos sanitarios en lotes grandes y turnos largos.
Dosis
Con aguja, la técnica de cada operario introduce variaciones de ángulo, profundidad y velocidad.
Con PULSE, la entrega es automática y estandarizada: el chorro penetra y dispersa el producto en un área tisular mayor, favoreciendo absorción y consistencia lote a lote.
Para protocolos exigentes (p. ej., inmunocastración) la repetibilidad marca la diferencia.
¿CÓMO FUNCIONA PULSE Y POR QUÉ TRABAJAR CON ÉL MARCA UNA
DIFERENCIA MEDIBLE?
PULSE se basa en un sistema neumático (aire comprimido o CO₂) que, al accionarse, genera un impulso de alta velocidad, creando una microapertura cutánea y empujando el volumen programado hacia el plano tisular elegido.
Ajustando la presión (según el modelo), se modula la profundidad para una administración intradérmica, subcutánea o intramuscular.
Todo sucede en menos de 0,2 s, lo que minimiza la reacción del animal y mantiene el ritmo de la línea.
Para el operario, la ausencia de aguja y el contacto estable de la boquilla reducen tensión, cambios de consumibles y microparadas.

Figura 1. Comparación entre la inyección convencional y el sistema
PULSE sin aguja: la presión controlada genera una microapertura cutánea y el chorro deposita y distribuye el fármaco de forma rápida, homogénea y en el plano tisular deseado (en menos de 0,2 s).
LA GAMA PULSE: TRES SOLUCIONES COMPLEMENTARIAS
PULSE 50 Micro Dose (0,1–0,5 ml)
Indicado para microdosis y procesado de lechones (hierro, antibióticos de baja dosis, intradermia en I+D).
Es una unidad de mano sin amplificador, con presión ajustable y tres seguros.
Su bajo desperdicio de imprimado y velocidad de chorro adecuada para pieles finas lo convierten en la herramienta adecuada para el primer ciclo de vida.
Si buscas administrar 0,1–0,5 ml con gran repetibilidad y consumo colateral mínimo, este es tu modelo.
PULSE 250 (0,5–2,5 ml)
Indicado para todas las edades y la mayoría de vacunas y tratamientos, incluida la administración intramuscular y subcutánea en transición y cebo.
Combina amplificador y pistola, y permite trabajar con accesorios específicos (lechón pequeño, lechón grande, manos libres, extensión), adaptando el contacto y la fuerza de apoyo al tamaño del animal.
Entrega 1–2,5 ml en menos de 200 ms, con una profundidad consistente, ideal cuando se superan cientos de inyecciones por turno y se necesita productividad por ciclo.
PULSE
FX (0,2–2,0 ml, dosis fija)
Indicado para porcinos de hasta 6 semanas y protocolos repetitivos a dosis fija.
Es ultraligero y no requiere juntas: se comporta como una jeringa desechable de larga duración (decenas de miles de disparos).
Disponible en dosis preajustadas (0,2 a 2,0 ml), el coste por dispositivo es ajustado y reduce el desperdicio en el cebado.
Requiere 10 bar de presión disponibles a cambio de simplificar el día a día de equipos pequeños o líneas con bajo volumen de inyecciones.
QUÉ MODELO ENCAJA
CONTIGO: TRES ESCENARIOS TIPO
1 2 3
Procesado de lechones (<10 días)
Si necesitas microdosis con ajuste fino y mínimo desperdicio, PULSE 50.
Si prefieres dosis fija, peso en mano mínimo y cero mantenimiento de juntas, PULSE FX.
Transición y cebo (1–2,5 ml IM/SC)
PULSE 250, con el accesorio adecuado al peso, mantiene un ritmo alto, constancia del plano tisular y ahorra tiempo cuando hay muchos animales que tratar.
Bajo volumen de inyecciones (<100/ semana) o equipos móviles
PULSE FX por simplicidad, coste y disminución del desperdicio.
PULSE 50 como alternativa cuando el rango 0,1–0,5 ml es la mejor elección.
BENEFICIOS QUE NOTARÁS DESDE EL PRIMER DÍA
VELOCIDAD Y FLUIDEZ
Los disparos sub-segundo mantienen la cadena en marcha. Así, en estaciones de procesado de lechones, las con guraciones manos libres reducen tiempos y fatiga: apoyar, sellar, accionar y pasar al siguiente.
Menos cambios de aguja.
Menos paradas.
Más animales por hora.
BIOSEGURIDAD Y SEGURIDAD DEL PERSONAL
Sin agujas:
Se elimina una de las principales vías de transmisión cruzada.
Se reducen los accidentes por pinchazo.
Desaparece el riesgo de cuerpos extraños por rotura de aguja, un punto crítico para auditorías y que genera grandes pérdidas por decomisos de canales.
PRODUCTIVIDAD MEDIBLE
El ahorro llega por varias vías:
Más inyecciones/hora.
Menos microincidencias.
Menos mermas por técnica irregular.
Menos bajas laborales.
Con el modelo adecuado al volumen de tu granja, el coste por inyección cae.
CONSISTENCIA DE DOSIS Y PLANO
La dispersión del chorro sobre mayor super cie tisular mejora la absorción y repetibilidad.
Al estar la presión regulada y el volumen controlado, se logran administraciones intradérmicas, subcutáneas o intramusculares con variaciones mínimas entre operarios y turnos.
Es el antídoto contra las variaciones en la técnica que lastran resultados.
BIENESTAR ANIMAL
La microapertura es notablemente más pequeña que la de una aguja y el disparo es instantáneo, por lo que el animal apenas reacciona.

Menos estrés en sala, menos forcejeos y menos sangrado super cial se traducen en manejos más tranquilos y recuperación más rápida.
AIRE COMPRIMIDO O CO₂: POTENCIA Y PORTABILIDAD SIN
BATERÍAS QUE FALLAN
Toda la gama PULSE es neumática y lo habitual en porcino es trabajar con compresor (8–9 bar para PULSE 50/250, 10 bar para FX), por disponibilidad y coste.
No obstante, cuando prima la portabilidad o no hay fácil acceso a electricidad, una botella de CO₂ resuelve.
Para elegir y utilizar bien la fuente de presión, conviene tener en cuenta tres reglas prácticas:
Intentar viabilizar aire antes de ir a CO₂.
Asegurarse de que la presión disponible supere holgadamente la requerida por el dispositivo.
Cuidar el sellado del accesorio sobre la piel para dirigir la energía al plano tisular correcto.
DESPERDICIO, CEBADO Y COSTE POR INYECCIÓN
El imprimado (llenado del circuito al inicio) consume producto.

En PULSE 250, la manguera de alta presión entre amplificador y pistola implica un mayor volumen a cebar. En jornadas con pocas inyecciones seguidas, ese desperdicio pesa.
PULSE 50 y PULSE FX generan menos merma en el arranque, por lo que son preferibles en situaciones de bajo volumen o en protocolos muy fragmentados.
A medida que crece el número de inyecciones por turno, el coste unitario disminuye y PULSE 250 destaca por su verdadera productividad.
INTEGRACIÓN EN TU FLUJO PORCINO: DE LA SALA DE PARTOS AL CEBO
Partos y lactación
Monta una estación manos libres con PULSE 50 o PULSE 250 (accesorio de lechón).
Jerarquiza tareas: hierro, antibióticos de baja dosis, primeras vacunas… Así, con un sellado correcto y presión ajustada, el ciclo se vuelve repetible y rápido.

Transición
Para 1–2,5 ml (vacunas y tratamientos subcutáneos e intramusculares), PULSE 250 es la opción versátil: profundidad predecible, disparo sub-segundo y menos manejo por animal.
Si el protocolo es siempre a dosis fija en animales jóvenes, FX simplifica la rutina.
Protocolos especiales
En inmunocastración u otros tratamientos exigentes por vía intramuscular, la estandarización de PULSE 250 aporta tranquilidad.
Para intradermia de baja dosis, PULSE 50 es la herramienta ideal.
Cebo
Cuando los animales crecen, el accesorio para grandes en PULSE 250 mejora el contacto y la estabilidad.
Planifica por lotes y organiza la línea para evitar esperas innecesarias, ya que la constancia de dosis reduce las repeticiones y fallos de cobertura.
RETORNO: DÓNDE
RECUPERAS LA INVERSIÓN Y CÓMO ACELERARLA
Tiempo y productividad 1
Más inyecciones/hora con menos paradas y sin incidentes típicos de la aguja (roturas, cambios, re-pinchazos).
2 3 4 5
Bioseguridad y seguridad laboral
Menos transmisión cruzada y menos pinchazos al personal se traducen en menos bajas y menos estrés.
Consistencia de dosis
Menos desviaciones por técnica variable, mejor respuesta inmunitaria y menos revacunaciones por fallos.
Desperdicio controlado
Elige el modelo según tu volumen: FX o 50 en bajo volumen; 250 en alto volumen. Minimiza el primado y estandariza el purgado para bajar coste por inyección.
Imagen y auditorías
Sin agujas, reduces el riesgo de cuerpos extraños en canales y facilitas la conformidad con protocolos de calidad, algo cada vez más valorado por integradoras y clientes.
de fármacos Administración










Sin Aguja
TOMA DE MUESTRAS A NIVEL DE CAMPO: EL PRIMER
ESLABÓN PARA ALCANZAR UN BUEN DIAGNÓSTICO LABORATORIAL
Gema Chacón y Mireya Melero
Exopol S.L.

El diagnóstico etiológico en la producción porcina ha tenido un desarrollo exponencial en las últimas décadas gracias al uso de nuevas técnicas laboratoriales de gran sensibilidad y especificidad.
Sin embargo, el primer paso para obtener un resultado fiable y preciso es la correcta toma de muestras, así, la calidad diagnóstica comienza en la granja. En este artículo se detallan los principios prácticos más relevantes para que los veterinarios de campo optimicen el proceso de muestreo según el caso clínico. Además, se explica la importancia de la correcta toma de muestras y de la elección de la técnica analítica más adecuada en función del objetivo diagnóstico.
Hay tres fases clave que estructuran el proceso de muestreo y que condicionan la calidad del diagnóstico desde el inicio:
Elección de la muestra.
Toma de la muestra.
Envío de la muestra.
ELECCIÓN DE LA MUESTRA
Seleccionar la muestra correcta condicionará el éxito del diagnóstico, por lo que se deberá estudiar el proceso presente en los animales, conocer el historial sanitario de la granja y con todo ello planificar el muestreo a realizar.
¿Qué muestras tomar?

¿Qué animales muestrear?
Aquellos con signos clínicos evidentes y representativos del proceso en curso.
Animales no tratados previamente con antibióticos.
Siempre que sea posible, varios individuos de distintos lotes o fases productivas.
En caso de muestreo post mórtem, animales recién muertos o sacrificados, nunca cadáveres con varias horas de evolución.
Para seleccionar la muestra a tomar se deben tener en cuenta varios condicionantes: El proceso clínico observado: respiratorio, nervioso, articular, digestivo, reproductivo, etc. (Tabla 1).
Técnicas a realizar
Procesos respiratorios
Procesos nerviosos
Poliserositis
Procesos articulares
Procesos digestivos
Procesos reproductivos
Procesos cutáneos X
(líquido cefalorraquídeo)
(líquido articular)
(serología Ascaris suum)
(raspado cutáneo profundo)
(septicemias)
(serología para Sarna sarcóptica)
Tabla

El estado del animal (Imagen 1).
IN VIVO
Es de gran interés tomar muestras de animales vivos con sintomatología característica, lo que permitirá un diagnóstico más amplio y representativo de la piara.
En este caso se seleccionarán muestras que no impliquen el sacrificio de los animales.
POST MÓRTEM
En caso de que haya bajas recientes de animales, se hará una necropsia reglada para poder obtener muestras de órganos o hisopados de los mismos.
IN VIVO


POST MÓRTEM

Articulaciones sin abrir

Imagen 1. Ejemplos de toma de muestras en vivo vs post mórtem.
El órgano diana del patógeno que se sospecha: es fundamental comprender la patogenia de la enfermedad que se desea diagnosticar, ya que ello permite seleccionar adecuadamente las muestras clínicas.
En la Tabla 2 se muestra, a modo de ejemplo, un cuadro resumen con las muestras idóneas en problemas nerviosos, de poliserositis y articulares en ganado porcino.
articular
Cabeza entera
Hisopo meninges
con fibrina
Tabla 2. Toma de muestras para el diagnóstico de los principales patógenos infecciosos causantes de problemas nerviosos, poliserositis y afecciones articulares en ganado porcino. No se incluyen enfermedades no presentes en España y/o sometidas a control oficial (Aujeszky, Peste Porcina Clásica y Peste Porcina Africana).
Líquido articular
Raspado broncoalveolar
Pulmón


DÉCIMA EDICIÓN
22 & 23 de abril 2026



La Llotja Lleida
La técnica diagnóstica a utilizar:
elección de la muestra también dependerá de la técnica diagnóstica que se vaya a emplear.
Por ejemplo, si se utilizan técnicas serológicas para evaluar la respuesta inmunitaria, se deberán enviar muestras de suero. En estos casos, es importante considerar el período de seroconversión, es decir, el intervalo entre el momento de la infección y la aparición de anticuerpos detectables en sangre.

El objetivo del análisis: no siempre se pretende identificar el patógeno. Según la finalidad concreta variarán tanto el tipo como el número de muestras a enviar.
Instaurar un tratamiento En procesos bacterianos es importante realizar antibiogramas para seleccionar el antibiótico más e caz.
Esto condiciona tanto la elección de las muestras —aquellas donde esté presente el microorganismo— como las condiciones de envío, que deben garantizar su viabilidad para permitir el aislamiento posterior.
Aplicación de medidas preventivas (vacunas o autovacunas)
Cuando la etiología ya es conocida, la nalidad es seleccionar la herramienta preventiva más adecuada. Para decidir entre una vacuna comercial o una autovacuna es necesario con rmar que la opción elegida protege frente al serotipo o variante presente en la explotación.
Esto suele requerir análisis de animales de distintos lotes y fases, así como técnicas diagnósticas que permitan el subtipado del patógeno.

Diagnóstico etiológico de un brote agudo de enfermedad En estos casos se seleccionarán muestras diana de animales con clínica instaurada, siendo idóneas las técnicas moleculares (PCR a tiempo real) por su precisión y rapidez
Control epidemiológico mediante monitorización de patógenos circulantes
Para esta nalidad son recomendables las muestras agregadas ( uidos orales) y ambientales (toallitas, calzas o muestras de aire).
El diseño debe contemplar tomas seriadas en distintos lotes y fases productivas para evaluar la presencia de patógenos y la introducción de nuevas cepas o variantes mediante secuenciación o tipado por qPCR, lo que permite identi car fallos de bioseguridad interna o externa.
diagnóstico

Errores frecuentes en la SELECCIÓN de la muestra
Muestrear animales crónicos o tratados.
Trabajar con cadáveres en avanzado estado de descomposición, ya que la autólisis impide un diagnóstico fiable.
Selección incorrecta de la muestra diana del patógeno que se quiere investigar.
Por ejemplo, en el diagnóstico de abortos por Erysipelothrix rhusiopathiae (Mal Rojo) o influenza porcina, los fetos no son la muestra idónea, ya que no se produce infección transplacentaria, sino que el aborto es consecuencia del cuadro sistémico febril que se genera en la cerda gestante. En ambos procesos, el diagnóstico debe centrarse en la madre: sueros para serología de influenza o Mal Rojo, muestras respiratorias (fluidos orales, hisopos nasales o traqueales) para qPCR de influenza o muestras de bazo, hígado o riñón de bajas en cerdas para cultivo microbiológico o qPCR de Erysipelothrix rhusiopathiae.
LA TOMA DE MUESTRA: TÉCNICA Y PROTOCOLO
¡Una muestra mal recogida es una oportunidad diagnóstica perdida!
Del mismo modo que cada técnica requiere un tipo de muestra específico, cada muestreo exige contar desde el principio con el material necesario para su obtención, manipulación y conservación.
La planificación previa es clave para evitar improvisaciones y garantizar que la muestra llegue al laboratorio en las mejores condiciones.
Asumir que una muestra es válida para cualquier técnica diagnóstica y para cualquier finalidad del análisis, cuando en realidad el objetivo marcará la técnica a utilizar y cada método requiere un tipo de muestra específico.
Por ejemplo, para el estudio de Actinobacillus pleuropneumoniae (APP) se puede enviar suero para realizar serología cuando el objetivo es evaluar exposición o infección previa. Sin embargo, si se pretende detectar la presencia actual de APP, se enviarán muestras como tejido pulmonar, fluidos orales o raspados traqueobronquiales para su análisis mediante qPCR. Por último, si se busca aislar la bacteria mediante cultivo microbiológico para el estudio de sensibilidad antibiótica, la muestra de elección es el pulmón.
Hay normas básicas que aplican a cualquier toma de muestra: Mantener la máxima asepsia: trabajar en un lugar limpio y utilizar guantes y material estéril.
Contar con el material adecuado para cada tipo de muestra.
Valorar si será necesaria la sujeción o sedación del animal en caso de toma in vivo.
Limpiar y desinfectar la zona de punción o corte para evitar contaminaciones.
En necropsias, cambiar guantes y bisturí entre muestras y evitar el contacto entre tejidos para reducir la contaminación cruzada.
Cada órgano, hisopo o fluido debe enviarse en su propio recipiente estéril, identificado de manera individual.


Por todo ello, antes de salir al campo hay que hacerse algunas preguntas clave:
¿De qué agente sospechamos?
¿Qué muestras serán más útiles?
¿Qué lesiones se prevé encontrar al abrir el animal?
Solo así se podrá preparar el material adecuado.
Para orientar este procedimiento, los laboratorios de diagnóstico suelen proporcionar guías o instrucciones específicas. Un ejemplo es la web de Exopol (exopol.com), donde están disponibles vídeos que muestran distintos protocolos de toma de muestras.
Errores frecuentes en la TOMA de muestras
Uso de material inapropiado. Algunos ejemplos serían el uso de hisopos sin medio de transporte para el aislamiento bacteriológico, ya que las bacterias pierden viabilidad, o el empleo de tubos con anticoagulante para realizar serología, dado que la mayoría de los kits serológicos no están validados en muestras de plasma.
Agrupar todas las muestras en un mismo envase, lo que provoca contaminación cruzada entre órganos.
Contaminación cruzada: ocurre al utilizar el mismo material (guantes, bisturí, tijeras) entre diferentes órganos o animales sin cambiarlo. Esto puede llevar a resultados falsos positivos o a la detección de patógenos que no se corresponden con la lesión de origen.
Mala identificación: etiquetas incompletas, confusas o que se despegan durante el transporte generan pérdidas de información.

diagnóstico

altas temperaturas.


que incluya antecedentes sanitarios, signos observados y tratamientos aplicados, de forma que el laboratorio pueda contextualizar los hallazgos y orientar el análisis.


Los órganos o fluidos biológicos deben refrigerarse cuando se vaya a solicitar un cultivo microbiológico, ya que la congelación disminuye la viabilidad bacteriana.

podrá identificar un patógeno, pero no sabrá si realmente está implicado en el cuadro clínico.



CONCLUSIÓN
La eficacia de un diagnóstico veterinario comienza mucho antes de que las muestras lleguen al laboratorio.
La elección del animal adecuado, la recogida correcta de las muestras más apropiadas y el envío en condiciones óptimas constituyen eslabones críticos de una misma cadena.
Formarse y sistematizar la toma de muestras es tan importante como interpretar un resultado.
diagnóstico

“JUNTOS LO HACEMOS POSIBLE”: LA INICIATIVA DE BOEHRINGER
INGELHEIM PARA
RESPALDAR
A
LOS PROFESIONALES
ANTE LOS NUEVOS DESAFÍOS DE LA INDUSTRIA

Con 140 años de historia, Boehringer Ingelheim es, hoy en día, una compañía global con presencia en 150 países de todo el mundo. Sin embargo, se trata de una empresa familiar que trabaja por y para la salud humana y animal.
Vinculados desde hace más de un siglo a la salud animal, el trabajo diario se materializa en el compromiso con la salud y el bienestar de los animales. Porque existe un vínculo único con los animales, pero también con las familias que les rodean: veterinarios, ganaderos, operarios de granja...
Juntos es la mejor manera de afrontar los nuevos retos de la industria.
JUNTOS HACEMOS FRENTE A LOS RETOS DEL FUTURO
Ahora, en un tiempo marcado por los cambios y la incertidumbre, los profesionales del sector porcino se enfrentan a cuestiones como:
El aumento de los costes.
La escasez de la mano de obra.
La amenaza de los nuevos patógenos.
La alta volatilidad global.
Además, temas como la responsabilidad ambiental, social y de gobernanza suponen nuevos desafíos que nos exigen, a todos, adaptarnos a los nuevos tiempos.
Ante esta realidad, Boehringer Ingelheim diseñó y puso en marcha una campaña impulsada por su compromiso con la mejora de la salud de los animales y por su responsabilidad con los veterinarios, una pieza clave para el buen funcionamiento y la evolución de la industria porcina.
JUNTOS LO HACEMOS POSIBLE
“Boehringer Ingelheim es una empresa familiar y eso hace que tengamos una forma de trabajar y de tomar decisiones que se aproxima mucho a todas esas empresas más familiares que tenemos presentes en el sector porcino. Esto nos permite trabajar mano a mano con nuestros clientes y socios, con quienes tenemos una relación muy cercana”.

Estos factores repercuten directamente en el día a día de su labor, pero también en la planificación a largo plazo de la industria porcina.
Gisela Girmé, responsable de marketing de Animales de Producción de Boehringer Ingelheim Animal Health España.
“Juntos lo hacemos posible” es una iniciativa del equipo de porcino de Boehringer Ingelheim que busca crear espacios de encuentro y colaboración con los profesionales del sector.
El objetivo es compartir conocimientos, ofrecer herramientas útiles para su día a día y poner a su disposición servicios que aporten valor real. En un momento de cambios y retos para la producción porcina, se tratar de estar cerca, acompañando y apoyando a quienes hacen posible que el sector siga avanzando.
Por encima de todos estos objetivos, hay uno que lo engloba todo: “Queremos arrojar luz en escenarios de incertidumbre y, entre todos, aportar soluciones que nos permitan optimizar nuestra rentabilidad en ambas direcciones”, afirma Gisela Girmé.
En este sentido, la campaña está dirigida a todas las personas que forman parte del sector porcino, “porque en Boehringer Ingelheim trabajamos con proyectos hoc para cada una de las situaciones y gracias a esto creamos escenarios de cooperación en la que no solo tratamos de buscar soluciones a los retos productivos relacionados con la salud de los animales, sino también a todos los desafíos a nivel empresarial”.

SIEMPRE AL LADO DE LOS PROFESIONALES
Durante todo este año 2025, “Juntos lo hacemos posible” ha desarrollado un sinfín de acciones para hacer hincapié en los pilares de esta campaña de responsabilidad y apoyo a los actores de la industria.
La iniciativa ha centrado la participación de Boehringer Ingelheim en eventos de referencia del sector como el Foro ANVEPI, PorciForum o ANAVEPOR. Pero más allá de esto, el equipo de Porcino de la compañía ha recorrido buena parte de la geografía española con la “Jornada Juntos lo hacemos posible”.
Esta acción formativa, dirigida específicamente a los profesionales del sector, ha recorrido lugares como Murcia, Reus, Zaragoza, Almendralejo, Salamanca, Valladolid, Lleida o Sevilla.
En todos ellos, se ha presentado un programa para actualizar los conocimientos de los asistentes y poder proporcionarles herramientas de utilidad en el desempeño de su labor.
Un programa en el que han intervenido expertos de la talla de Jordi Baliellas, Ramsés Reina, Manolo Toledo, Miguel Ángel Higuera o Héctor Argüello, entre otros.
De la mano de colaboradores como Sumgasur, Nuserga, SNG, Céntesis, Nutrofar, Leonvet, Zoomedic y Lleidam, se han abordado cuestiones clave para la industria porcina.
Y es que es más importante que nunca establecer sinergias y reforzar los lazos con los distintos actores de la industria sin olvidar que en el centro están ubicados los veterinarios y ganaderos.
Para ellos, en estas jornadas se han programada ponencias en las que se ha profundizado en cuestiones como la salud digestiva, la salud intestinal, el control de la ileítis porcina, la actualización de la cepa Rosalía, el manejo y el control del PRRS, el liderazgo rural, el bienestar animal o la transferencia de la inmunidad pasiva y su influencia en la vacunación.
Porque en Boehringer Ingelheim, juntos lo hacemos posible.
“Juntos lo hacemos posible”: la iniciativa de Boehringer Ingelheim para respaldar a los profesionales ante los nuevos desafíos de la industria DESCÁRGALO EN PDF ACCEDER A SOLOPORCINO.ES

Juntos lo hacemos posible
Una verdadera alianza se construye abordado juntos los desafíos de forma integral. Llevamos 30 años poniendo a los profesionales del sector en el centro. Por eso hemos desarrollado vacunas, servicios y tecnologías punteras, herramientas eficientes pensadas para hacer tu negocio sostenible en el tiempo.
Siempre pensando en ti

VIGILANCIA DE RESISTENCIAS EN BACTERIAS PATÓGENAS
CLÍNICAS: HERRAMIENTA
CLAVE PARA LA PRESCRIPCIÓN
RESPONSABLE DE
ANTIBIÓTICOS EN VETERINARIA
1Técnico científico del PRAN en Sanidad Animal
2Coordinadora del PRAN en Sanidad Animal
La resistencia a los antimicrobianos (RAM) es uno de los mayores desafíos sanitarios de nuestro tiempo que compromete la eficacia de los tratamientos, eleva los costes sanitarios y representa una amenaza para la salud humana, animal y medioambiental.
La vigilancia de la RAM en animales enfermos es esencial para:
Identificar patrones de resistencia.
Evaluar la prevalencia de resistencias.
Detectar resistencias clínicamente relevantes o emergentes.
Además, permite orientar medidas políticas ajustadas y adaptar la prescripción antibiótica con el fin de mejorar los resultados terapéuticos, así como constituir una herramienta de apoyo en los Programas de Optimización del Uso de Antimicrobianos (PROA).
En el contexto actual, esta vigilancia no es un lujo, sino una necesidad.
Cristiana Teixeira Justo1, Cristina Muñoz 2 y María J. Vilar1

En este sentido, el Proyecto de Vigilancia de Bacterias Patógenas Clínicas del Plan Nacional frente a la Resistencia a los Antibióticos (PRAN) representa un avance estratégico para la clínica veterinaria.
Esta herramienta interactiva, alimentada por laboratorios de diagnóstico adheridos voluntariamente, permite consultar datos actualizados por especie, región, bacteria y antibiótico, mejorando la precisión terapéutica y apoyando la toma de decisiones clínicas.
Proyecto de Vigilancia de Bacterias Patógenas Clínicas
Su conexión con iniciativas europeas como EARS-Vet refuerza su valor como sistema armonizado de vigilancia.
A continuación, se presenta este proyecto, su funcionamiento, cómo pueden implicarse los veterinarios clínicos y su especial relevancia en el contexto de la sanidad porcina en España.
ESPAÑA EN EL CONTEXTO EUROPEO: COLABORACIÓN CON EARS-VET
El proyecto español se alinea con la red de vigilancia europea de RAM en bacterias patógenas clínicas de animales (EARS-Vet, European Antimicrobial Resistance Surveillance Network in Veterinary Medicine).
Esta red surge con la primera acción conjunta europea en RAM e infecciones relacionadas con la asistencia sanitaria (IRA) (EU-JAMRAI) y trata de establecer una red de sistemas de vigilancia nacionales con el objetivo de:
Informar sobre la situación de las resistencias antimicrobianas.
Seguir tendencias e identi car RAM emergente en bacterias patógenas de animales en Europa.
ACCEDER A EARS-VET / EU-JAMRAI

Pretende complementar los sistemas actuales de vigilancia de consumo y de resistencia, incluyendo especies animales, bacterias patógenas y antibióticos de relevancia en veterinaria y en medicina humana (como la resistencia a las carbapenemasas).
Además, permite la integración con datos de consumo y vigilancia del sector humano y medioambiental (como, por ejemplo, el informe JIACRA).
En la actualidad participan 38 instituciones de 18 países y organismos internacionales, entre los que se encuentran:
La Autoridad Europea de Seguridad Alimentaria (EFSA).
El Centro Europeo para la Prevención y el Control de las Enfermedades (ECDC).
La Federación de Veterinarios de Europa (FVE).
La Organización de las Naciones Unidas para la Alimentación y la Agricultura (FAO).
UNA HERRAMIENTA PRÁCTICA PARA LA CLÍNICA VETERINARIA

La Organización Mundial de Sanidad Animal (OMSA).
La Organización Mundial de la Salud (OMS).
Reuniendo a los actores involucrados en los sistemas de vigilancia nacionales e internacionales, EARS-Vet busca actuar como centro de conocimiento para la vigilancia de la RAM en patógenos bacterianos animales y proporcionar orientación sobre los métodos y estándares que deben utilizarse, facilitando así la calidad, la armonización y la comparabilidad de los datos.
Gracias a la participación en EARS-Vet, los datos de RAM recogidos en el Proyecto de Vigilancia de Bacterias Patógenas Clínicas son comparables con los de otros países europeos, lo que permite detectar tendencias continentales, resistencias emergentes y evaluar políticas de uso de antibióticos a gran escala.

El Mapa Epidemiológico desarrollado por el PRAN es una herramienta de acceso restringido para usuarios registrados (veterinarios clínicos o laboratorios) y está diseñada específicamente para facilitar una prescripción más racional de antibióticos. Su utilidad es múltiple:
Apoyo a la elección empírica de antibióticos: basada en datos actuales y agregados de sensibilidad.
Reducción del uso de antibióticos críticos para la salud humana.
Justi cación de tratamientos o de la utilización de determinadas categorías de antibióticos.
Fomento de la rotación de principios activos, evitando la selección de resistencias.
Evaluación de resultados terapéuticos en base a patrones locales o nacionales.

El Mapa Epidemiológico es una herramienta digital interactiva que representa un puente entre:



La microbiología diagnóstica
La toma de decisiones empírica
Probablemente será una herramienta indispensable en la clínica veterinaria del futuro, donde los profesionales pueden consultar información epidemiológica detallada, como:
La frecuencia de aislamiento en el tiempo por región, especie animal y bacteria.
Los porcentajes de sensibilidad para diferentes antibióticos.
La información epidemiológica útil para todos los casos clínicos producidos por el mismo agente patógeno, siempre que se pueda establecer un nexo epidemiológico.
La distribución geográfica de los datos.
Actualmente, hay 23 laboratorios adheridos al proyecto, distribuidos por todo el territorio nacional y especializados en todos los sectores de la clínica veterinaria.

agregada y anonimizada, se presenta en forma de gráficos, mapas y tablas comparativas de fácil interpretación para el veterinario clínico.
Figura 1. Pantalla de búsqueda del Mapa Epidemiológico del PRAN.

La participación en este sistema refuerza el compromiso de la sanidad animal española con la salud pública global.
1
las granjas o pueden registrarse través de los colaboradores, muestras clínicas y al sistema. 2
Los veterinarios, las granjas o las empresas pueden registrarse en el proyecto a través de los laboratorios colaboradores, enviando muestras clínicas y aportando datos al sistema.
2
Una vez dado de alta, el veterinario tendrá acceso a sus datos y a los datos agregados a nivel comarcal, autonómico y nacional. Esto permite detectar tendencias de forma temprana a nivel de granja o clínica, implementando medidas especí cas y facilitando la toma de decisión de un tratamiento antibiótico.
IMPACTO EN EL SECTOR PORCINO
ESPAÑOL
La producción porcina es uno de los sectores más relevantes de la ganadería española y también uno de los que más antimicrobianos ha consumido históricamente.
No obstante, también es uno de los sectores que más ha contribuido a la reducción del consumo de antibióticos, especialmente de antibióticos críticos como la colistina.
Gracias a la colaboración de todo el sector con el Programa Reduce Colistina, el consumo actual de este antibiótico en España es casi inexistente.
Una vez dado de alta, el veterinario tendrá acceso a sus datos y a los datos agregados a nivel comarcal, autonómico y nacional. Esto permite detectar tendencias de forma temprana a nivel de granja o clínica, implementando medidas especí cas y facilitando la toma de decisión de un tratamiento antibiótico.
La utilidad de esta herramienta es especialmente relevante en aquellas situaciones en las que no sea posible esperar a un diagnóstico microbiológico y a la determinación de la sensibilidad antimicrobiana para la instauración de un tratamiento.
Además, fomenta la vigilancia activa en casos de fracaso terapéutico o infecciones recurrentes.
Con el Mapa Epidemiológico podemos constatar que ese esfuerzo se ve recompensado mediante resultados, ya que actualmente se detecta una reducción importante en el porcentaje de bacterias resistentes a colistina, como en la diarrea postdestete, patología que más ha contribuido al uso de este antibiótico en este sector.

ACCEDER A Programas de reducción en sanidad animal

SENSIBILIDAD A LA COLISTINA EN PORCINO
(agosto 2024 a agosto 2025)
Salmonella Spp.
Escherichia coli beta-hemolítica

Escherichia coli

Actinobacillus pleuropneumoniae
Clostridium perfringens
Actinobacillus suis
Escherichia coli

Figura 2. Datos nacionales de sensibilidad a la colistina en porcino para los principales agentes etiológicos de la diarrea, en el último año (agosto 2024 a agosto 2025).
Este es un claro ejemplo de las potencialidades de esta herramienta y de la aplicación de la información epidemiológica que, junto con los datos de uso de antimicrobianos, busca apoyar la implementación de los Programas PROA en el ámbito veterinario.
Esta línea de trabajo se alinea con uno de los objetivos marcados para el nuevo PRAN en sanidad animal y con las nuevas iniciativas que están comenzando a surgir en Europa.

Escherichia coli beta-hemolítica
Glaesserella parasuis
Pasteurella multocida
Samonella sp.
Staphylococcus aureus
Staphylococcus chromogenes
Staphylococcus hyicus
Staphylococcus suis
Trueperella pyogenes
Bordetella bronchiseptia
Escala de sensibilidad


El proyecto de vigilancia tiene un valor especial en este ámbito por varias razones:
Recopila datos nacionales y regionales que permiten identificar patrones de resistencia en infecciones frecuentes en cada uno de los sectores de producción.
Permite adaptar las guías terapéuticas a la situación epidemiológica.
Facilita la concienciación y la formación continuada de los actores implicados al utilizar los datos como argumento de peso.
Apoya la aplicación de medidas de manejo y bioseguridad específicas.
Favorece la aplicación de tratamientos más dirigidos al uso prudente de antibióticos.
Gracias a toda esta información, es posible reducir aún más el uso innecesario de antimicrobianos, preservar su eficacia y mejorar los resultados productivos.
En definitiva, el Mapa Epidemiológico es una herramienta valiosa y necesaria para la medicina veterinaria del siglo XXI.
Su implementación práctica permite tomar decisiones más informadas, reducir la presión selectiva y avanzar hacia un uso verdaderamente responsable de los antibióticos.
Es por ello que la implicación activa de los veterinarios clínicos, ganaderos y empresas porcinas — como usuarios y como promotores del sistema— es esencial para garantizar su éxito.
En un contexto como el de la producción porcina española, esta herramienta ofrece una oportunidad concreta para mejorar la sanidad animal y proteger la salud pública.

Vigilancia de resistencias en bacterias patógenas clínicas: herramienta clave para la prescripción responsable de


Rota+Coli+Clos

ÚNICA EN
SU ESPECIE
AHORA EN DOS
5 DOSIS
25 DOSIS
TRIPLE PROTECCIÓN EN CADA DOSIS
EXCELENTE PERFIL DE SEGURIDAD


CLAVES PARA UN MANEJO ÓPTIMO DEL PROCESO DE VACUNACIÓN EN LECHONES
Fernando Cerro Servicio Técnico porcino de Ceva

En el marco de las estrategias sanitarias para el control de las enfermedades que afectan a la especie porcina, las vacunas son hoy por hoy una de las herramientas clave para la reducción del uso de antimicrobianos dentro de la producción porcina, así como para optimizar la prevención de enfermedades.
Para establecer cualquier protocolo vacunal con las diferentes vacunas disponibles es necesario tener en cuenta todos aquellos factores que pueden afectar a la eficacia de una vacuna, ya que no considerarlos tiene como resultado los diversos grados de eficacia frente a la enfermedad a prevenir que se pueden observar a nivel práctico mediante el uso de vacunas.
Figura 1. Relación entre la inversión en vacunación y el impacto económico de la enfermedad.
Uno de los factores más importantes y en ocasiones el más olvidado es el propio proceso de la vacunación.
Identificar los puntos críticos, proponer medidas correctoras y monitorizar el proceso de vacunación constituyen las bases para optimizar la inmunización de los animales.
Inversión en vacunas: 4 % del coste de producción
Enfermedad (mortalidad, tratamientos, oportunidad, etc.)

¿CUÁNDO EMPIEZA LA VACUNACIÓN?
Al contrario de lo que podamos pensar, el proceso de vacunación no empieza al inyectar al primer lechón, sino que comienza cuando la vacuna llega a la granja y se recibe y almacena correctamente.
ALMACENAMIENTO CORRECTO DE LAS VACUNAS
Una vacuna es un producto termolábil y fotosensible, por lo que necesita ser almacenada en condiciones de temperatura adecuadas y protegida de la luz solar.
Por tanto, se debe asegurar que siempre esté almacenada en un rango de entre 2 °C y 8 °C para su correcta conservación.
Se necesitará una nevera en la que únicamente se almacenen vacunas o, como mucho, productos de uso veterinario que necesiten ser almacenados en frío.
Es importante evitar a toda costa almacenar comida o bebida para reducir la probabilidad de contaminación.
A nivel de distribución en la nevera:
Se debe dejar espacio entre los viales (1 cm) para que circule el aire frío y todos los elementos alcancen la temperatura deseada.
Se debe evitar que los viales toquen las paredes o el fondo de la nevera (ya que pueden congelarse y deberán desecharse).
Se debe evitar utilizar la puerta de la nevera para almacenaje, ya que es el punto que más difícilmente alcanzará la temperatura deseada.
Es ideal utilizar acumuladores de frío para ayudar a conservar la temperatura óptima de almacenamiento.
Por último, se debe organizar la nevera según la fecha de caducidad de los productos, colocando hacia fuera los viales que estén más próximos a caducar cuando se reciban nuevos pedidos de vacuna en la granja.
Paquetes fríos (puestos a congelar)
Paquetes fríos (congelar)
Bandeja de deshielo
Vacunas
Termómetro
Paquetes fríos (puestos a enfriar)


Esto solo es posible si la carga de la nevera no es demasiado elevada, por lo que, si se necesita almacenar muchos viales, lo ideal es disponer de varias neveras para el almacenaje.
Figura 2. Distribución ideal en la nevera para el almacenamiento de vacunas con separación entre viales, uso de acumuladores de frío, control de la temperatura y organización según fecha de caducidad para garantizar su correcta conservación.
2-8 °C

ANTES DE VACUNAR: ASIGNACIÓN DE TAREAS
Previo a la vacunación, cada persona debe tener claro su rol en el proceso y conocer qué tareas va a desempeñar.
La importancia de la vacunación para los resultados productivos debe motivar a destinar el personal necesario y a organizar las sesiones en función de la carga de trabajo.
PREPARACIÓN DE LA VACUNA Y MATERIAL DE VACUNACIÓN
En este apartado hay varias preguntas que se deben plantear:
¿Cuántos animales se van a vacunar?
¿Qué edad tienen?
¿Qué tamaño de aguja necesitan?
¿Qué tipo de jeringuillas se emplean para vacunar?
¿Cómo se atempera correctamente la vacuna?
Cantidad de animales a vacunar
Dependiendo de las dimensiones de la granja, la recomendación general es preparar dosis para un 80 % de los animales y, posteriormente, según el tiempo disponible y los animales restantes, ajustar el número de dosis con precisión.
El uso de botellas o mochilas es una práctica muy extendida en granjas medianas y grandes, pero se debe asegurar que el material esté perfectamente limpio y que el llenado de la garrafa se realice en condiciones higiénicas, con un lavado de manos previo y con guantes de látex limpios para manipular los viales de vacuna.
Edad
de los animales y tamaño de aguja
Según la edad del animal en el momento de ser vacunado, se necesitará un tamaño u otro de aguja con el fin de que el producto quede correctamente depositado en la musculatura del cuello. Como norma general:
Lechones de 3 semanas: 15mm * 13 Ø
Lechones de 7 semanas: 25mm * 16 Ø
Lechones de 10 semanas: 30 mm * 18 Ø
¿Qué tipo de material se emplea?
Conviene recalcar que la vacunación es una tarea de gran importancia para el productor y, por tanto, merece que se destine material exclusivamente para ella.
Es importante:
Usar jeringuillas limpias y bien calibradas.
Comprobar siempre su dosificación correcta antes de utilizarlas e, idealmente, también a mitad y al final de la vacunación, ya que es clave para su eficacia.
Atemperado correcto de las vacunas
El producto vacunal debe atemperarse antes de inyectarse en el animal.
La vacuna se atempera para que el producto penetre adecuadamente en la musculatura y cause menos molestia al animal.
1h–1h30min
Lo ideal es tener planificada la hora de inicio de la sesión de vacunación de manera que se puedan sacar los viales de la nevera con suficiente antelación (1 h–1 h 30 min) y dejarlos atemperar lentamente, con el fin de que alcancen la temperatura de la sala.
El objetivo es que el producto vacunal alcance una temperatura de unos 20-25 °C. Esta es la temperatura ideal a la que los productos vacunales deben inyectarse al animal.

Figura 3. Atemperado de viales de vacuna para que alcancen la temperatura ideal de inyección (20–25 °C), garantizando una correcta administración y reduciendo las molestias en el animal.
Reconstitución de la vacuna
En el caso de que el producto vacunal necesite ser reconstituido, como norma general se deben seguir las mismas medidas de higiene mencionadas anteriormente, atemperando ambas fracciones (liofilizado y diluyente) y reconstituyendo el producto mezclando el diluyente con la parte liofilizada antes de inyectarlo.
Para ello, existen dispositivos que perforan ambos viales y transfieren el líquido de uno a otro de forma higiénica.
No es recomendable, en ningún caso, abrir todos los viales y mezclarlos directamente en la botella o garrafa.

Figura 4. Dispositivo para la reconstitución higiénica de vacunas, diseñados para perforar ambos viales y transferir el diluyente al liofilizado sin necesidad de abrirlos ni manipularlos directamente.

Mezcla de la vacuna con otros productos
La vacuna únicamente se puede mezclar con productos que aparezcan en su ficha técnica y que estén registrados para esa finalidad.
Es una práctica común mezclar la vacuna con otros productos para evitar un manejo adicional, pero, se debe asegurar que dicha mezcla esté registrada y permitida para garantizar la estabilidad de los productos tras la combinación.
APLICACIÓN DE LA VACUNA EN LOS ANIMALES
La pregunta que surge ahora es:
¿Cómo se puede asegurar que la vacuna se aplique correctamente?
No es una pregunta sencilla, ya que dependerá de varios factores:
Inmovilización
La correcta inmovilización del animal es muy importante.
Existen granjas que emplean alargadores o vacunan con los animales en el suelo, etc., pero, en la medida de lo posible, se debe alzar al animal en brazos e inmovilizarlo.
20-25°C
Una forma adecuada de hacerlo es inmovilizando la pata delantera derecha del animal contra el cuerpo, sujetándolo por debajo de la mandíbula y exponiendo así el área de las tablas del cuello.


Se debe asegurar una correcta inmovilización del animal y realizar la inyección de forma perpendicular al cuello, introduciendo, inyectando y retirando la aguja antes de cargar de nuevo el producto.
Si el ritmo de vacunación es alto, es posible que alguna de las inyecciones quede demasiado superficial.
Si hay reflujo en el punto de inyección, es recomendable revacunar al animal.
Figura 5. Inmovilización correcta del lechón durante la vacunación, sujetando la pata delantera derecha contra el cuerpo y sosteniendo la mandíbula para exponer adecuadamente la zona de inyección en las tablas del cuello.
Para ello, es importante que el equipo de vacunación esté compuesto, al menos, por dos personas: una que alce e inmovilice al animal y otra que inyecte el producto y compruebe visualmente que no haya reflujo en el punto de inyección.
En caso de que, por el peso del animal, sea difícil levantarlo, el uso de tableros o separadores es útil para inmovilizar a un grupo de animales, vacunarlos y marcarlos, comprobando siempre que no exista reflujo de vacuna en el punto de inyección.
Comprobación del reflujo
El reflujo consiste en la salida accidental de vacuna por el orificio generado al inyectar el producto.
Esto no es deseable en ningún caso, ya que lo ideal es que se aplique la dosis completa.
Para evitar el reflujo, es recomendable, en primer lugar, elegir un tamaño de aguja adecuado a la edad y el peso del animal.
Agrupado de animales
Una medida que permite ahorrar mucho tiempo y personal en las vacunaciones es el agrupado de los animales.
Una buena opción en las maternidades es utilizar un tablero fijado al slat y al corral con ganchos o pletinas en forma de L, que permita agrupar a los lechones en un lado del corral para ir vacunándolos y soltándolos.
Esto permite ahorrar una gran cantidad de tiempo y trabajo. Sin embargo, cada granja es diferente y es necesario adaptar estos sistemas a cada caso.
Cambio de aguja
Este es un aspecto importante. Cada camada es un grupo de animales separado del resto por una barrera física.
Tras el nacimiento, los lechones se igualan y agrupan después de permanecer con su madre el tiempo suficiente para asegurar el encalostrado. Durante la lactación, estos lechones conviven e interactúan directamente con sus compañeros de camada.
Es por esto por lo que el cambio de aguja debería realizarse entre cada camada, para eliminar el riesgo de transmisión de enfermedades infecciosas (por ejemplo, PRRS) a través de agujas contaminadas.

En relación con este punto, un cambio de aguja con la frecuencia adecuada tendrá un impacto positivo sobre el bienestar animal del lechón, ya que reducirá el daño en la piel y en el tejido subcutáneo que experimente el animal, dado que la aguja va perdiendo filo y volviéndose roma, como se aprecia en la Figura 6.
Después de la aplicación de la vacuna, existen una serie de pasos que permiten asegurar que el equipo de vacunación queda listo para la siguiente sesión y que se lleva un control y una trazabilidad adecuados de las sesiones de vacunación.
Limpieza de los equipos
Es importante limpiar bien todos los equipos de vacunación con agua tibia y jabón y, posteriormente, aclararlos con agua para eliminar los restos de producto vacunal y de materia orgánica.
También es importante, en este momento, seguir las recomendaciones de mantenimiento de los componentes que lo requieran, así como cambiar el material fungible (garrafas, tubos, etc.) con la frecuencia adecuada y eliminar el material desechable de forma correcta, sin reutilizarlo nunca entre vacunaciones.



Aguja nueva 20 animales 50 animales
Figura 6. Desgaste progresivo de la aguja tras su uso en diferentes números de animales. A medida que aumenta el uso, la punta pierde filo y se vuelve más roma, incrementando el riesgo de causar daño en la piel y en el tejido subcutáneo del lechón.
LIMPIEZA Y DESINFECCIÓN DE LOS EQUIPOS Y GESTIÓN DE DOSIS SOBRANTES
Gestión de las dosis sobrantes
Una de las preguntas más comunes en este punto es: ¿qué hago con las dosis que han sobrado?, ¿se pueden volver a guardar en la nevera? Esta pregunta, como norma general, tiene una respuesta muy clara:
No se pueden guardar dosis sobrantes entre vacunaciones, por lo que deben desecharse.
Las dosis que pierdan la cadena de frío deben utilizarse dentro del período establecido por el fabricante.
Estas cuestiones casi siempre están relacionadas con que las vacunas vienen en formatos de volumen concretos y, al haber picos de animales, no se pueden dejar sin vacunar, lo que a veces “obliga” a abrir otro frasco… ¿o no?
vacunación
Pero no es así:
Se pueden extraer, con una jeringa y aguja estériles, únicamente las dosis necesarias directamente del frasco y volver a introducirlo en la nevera para que no pierda la cadena de frío.
Esta medida se puede aplicar siempre y cuando la presentación del producto vacunal no requiera una reconstitución previa, ya que, una vez reconstituido, el producto debe utilizarse dentro del tiempo establecido por el fabricante.
FIN DE LA VACUNACIÓN: REGISTRO DE LAS ACCIONES
Es recomendable llevar un registro de las acciones realizadas en el proceso de vacunación, con el fin de trazar correctamente este procedimiento y poder acudir a esta información en el futuro.
Un buen registro de la vacunación debería incluir:
Empresa, explotación y código REGA.
Fecha de vacunación.
Identificación del lote de animales.
Número total de animales vacunados.
Edad de los animales / momento de vacunación.
Producto aplicado: nombre comercial, número de lote.
Personas implicadas.
Comentarios.
En Ceva somos expertos en asesorar y orientar a nuestros clientes sobre la mejor forma de llevar a cabo sus vacunaciones, realizando auditorías a la vacunación en granja (P.I.G. Program, Vaccinomics) en las cuales identificamos los puntos que afectan a la calidad del proceso y el impacto que pueden tener y proponemos medidas para mejorar cada uno de estos puntos y alcanzar una vacunación de calidad en los animales.
Si quieres más información no dudes en contactar con el Equipo de Ceva ceva.salud-animal@ceva.com
CLAVES PARA UNA VACUNACIÓN EXITOSA
Para finalizar este artículo sobre el manejo de la vacunación en lechones, se presentan a continuación varias take-home messages, que recogen las ideas clave del documento y permiten mejorar el proceso de vacunación.
La vacunación es una tarea física y rutinaria, por lo que es fácil que se descuide. Es fundamental otorgarle la importancia que merece y destinar los recursos necesarios.
Un lechón bien vacunado afrontará de forma óptima los desafíos que encontrará a lo largo de su vida productiva.
La vacunación comienza cuando la vacuna llega a la granja y finaliza con el registro de las acciones realizadas durante el proceso. Cada paso es importante.
Antes de iniciar la vacunación, se deben definir con claridad los roles y responsabilidades de cada persona y destinar los recursos adecuados.
Un equipo de al menos dos personas es esencial para una vacunación correcta, ya que permite alzar e inmovilizar a los animales adecuadamente e inyectar las dosis en el punto indicado.
El atemperado de las vacunas es un paso clave para su correcto uso.
Es fundamental utilizar equipos de vacunación limpios, calibrados y ajustados, así como comprobar con frecuencia la dosis administrada.
Destinar 10 minutos tras la vacunación al registro de las acciones realizadas proporciona información de gran valor para futuras sesiones.
Claves para un manejo óptimo del proceso de vacunación en lechones DESCÁRGALO EN PDF
Ya no lo decimos nosotros.
Ahora lo dicen los lechones.































































El Síndrome de Dermatitis Ulcerativa Porcina (PUDS, Porcine Ulcerative Dermatitis Syndrome), hace referencia a un desorden crónico y de aparición esporádica en animales adultos, cuyo origen, sigue sin estar bien definido.
Los estudios y artículos al respecto son pocos y están realizados sobre un número reducido de animales, a menudo solo uno.
Hay casos descritos desde hace muchos años, pero hoy en día sigue siendo una alteración sobre la que hay muchas lagunas, tanto en lo referente a su etiología y patogénesis como a los factores relacionados. De hecho, su nomenclatura actual fue propuesta en 2004 por Schmoll1 en un artículo en el que se pretendía diferenciarla de la dermatitis ulcerativa de origen bacteriano.
SÍNDROME DE DERMATITIS
ULCERATIVA EN CERDAS: ¿TE SUENA?
PRESENTACIÓN CLÍNICA DEL PUDS
La presentación clínica de este proceso es muy llamativa, observándose zonas de piel hiperémicas, mayoritariamente en la región mamaria, aunque también pueden presentarse en los flancos, muslos, base de la cola, zona perineal y orejas.
Curiosamente, el pezón no se ve afectado, aunque toda la piel de alrededor sí lo esté y, por tanto, no se compromete su funcionalidad.
Imagen 1. Típica manifestación del PUDS, sin afectación del pezón.

Paula Sánchez Giménez Técnico Veterinario CEFU S.A.


Imágenes 2 y 3. Otras localizaciones de lesiones asociadas a PUDS en vulva y los flancos.
Las áreas afectadas aparecen como úlceras de tamaño variable, con los bordes bien delimitados y delgados, que no sobresalen de la superficie, aunque a veces hay descamación alrededor.
Comienzan como nódulos blanquecinos que terminan ulcerándose, con una forma más o menos redondeada, que acaban confluyendo y extendiéndose.
Los animales presentan una temperatura corporal normal o algo disminuida y se ven bien, quizá algo anémicos en algún caso, y en general mantienen una buena condición corporal. No se describen más signos clínicos.
Suele verse en animales al final de la gestación o al inicio de la lactación, y las lesiones tienden a desaparecer durante la lactancia o el postdestete, aunque no responden a tratamientos con antibióticos y/o antiinflamatorios.
No se ha establecido relación con el ciclo productivo de la cerda.
Tabla 1. Ejemplo de variedad de ciclos de presentación y temperaturas de los animales afectados, todos ellos en la fase periparto (Fuente propia).

Imagen 4. Cerda lactante afectada con PUDS.
DIAGNÓSTICO DEL PUDS
En este caso, hay que basarse en:
La evidencia de las lesiones tan características.
La edad y el momento del ciclo productivo en que se encuentra el animal.
La falta de respuesta a cualquier tratamiento que se haya podido aplicar.
El diagnóstico diferencial debe hacerse con:
Dermatitis de origen bacteriano (que responderían al tratamiento antibiótico).
Intoxicación.
Quemaduras.
Síndrome de dermatitis y nefropatía.
Otras patologías mucho menos comunes, como el pénfigo o la epidermólisis.
También deben descartarse las enfermedades vesiculares que afectan al porcino2
En el caso de realizar un raspado cutáneo de la lesión, es posible encontrar bacterias ubicuas de la piel, como Staphylococcus hyicus, en baja o media cantidad, sin que tengan importancia clínica en estos casos.
Número
Enzimas hepáticas
Hematocrito/hemoglobina
Leucocitos
Histopatología
A nivel histopatológico se describen:
Áreas de necrosis en la epidermis con zonas ulceradas, bajo las que se observa un infiltrado inflamatorio mixto (linfocitos, neutrófilos y macrófagos).
Adyacentes a las zonas ulceradas, áreas con hiperplasia del epitelio con hiperqueratosis, células del estrato basal con degeneración hidrópica y queratinocitos apoptóticos en distintos niveles de la epidermis.
Debajo de las zonas con hiperplasia, infiltrado inflamatorio concentrado en la unión dermoepidérmica, compuesto principalmente por linfocitos 3
Bioquímica
En lo que respecta a los análisis de parámetros bioquímicos, no hay unanimidad en los resultados publicados en la literatura.
Un claro ejemplo se muestra en la Tabla 2, donde se obtuvieron resultados distintos en tres artículos diferentes.
Atendiendo a estos datos, se aprecia que aún queda mucho por estudiar en cuanto a los valores hematológicos y bioquímicos de los animales con PUDS.
Aumento leve o moderado Normal (urea leve disminución)
Ligera anemia
Normal (ligera linfopenia)
Disminución leve
Normal (ligera linfopenia)
*Trabajo comparando resultados entre un grupo afectado de PUDS y otro control
Sin diferencias entre grupos (disminución ligera AST y albúmina)
Sin diferencias entre grupos (ambos algo disminuidos)
Sin diferencias entre grupos (leve disminución basófilos)
Tabla 2. Resultados de tres estudios que evaluaron parámetros bioquímicos en cerdas con PUDS, mostrando la variabilidad observada entre ellos.

Trabajo
Schmoll et al., 2004
López et al., 2009
Sánchez-Giménez et al., 2021*
Inmunohistoquímica
No se han detectado marcadores de apoptosis 3 .
En cuanto a los niveles de IgG, se han obtenido resultados distintos dependiendo de la técnica utilizada y del estudio consultado.
Se describen niveles de IgG determinados por inmunodifusión elevados de dos a cuatro veces en todas las cerdas afectadas en comparación con animales sanos.
No se han detectado depósitos de IgG utilizando la técnica de inmunofluorescencia (IF) directa y tampoco se pudieron demostrar autoanticuerpos IgG circulantes en muestras de suero mediante un método de IF indirecta en un trabajo de 2016, aunque sí se observó un patrón lineal de precipitación de IgG a nivel de la membrana basal en otro de 20094,5 .
Serología y aislamiento vírico
En todo el material publicado se coincide en que son animales que no presentan resultados compatibles con infecciones activas por virus como PRRSv, PCV2 o PPC, ni con patologías de origen bacteriano como Mal Rojo1,5
RESOLUCIÓN DE LAS LESIONES ASOCIADOS AL PUDS
El PUDS no responde a ningún tipo de tratamiento. De hecho, ni siquiera se observa efecto tras el tratamiento con corticoides, que son de elección ante trastornos autoinmunes.
Generalmente, las lesiones se resuelven solas al cabo de 4-8 semanas, aunque se han descrito recidivas en animales en distintos ciclos consecutivos 4



Imágenes 5, 6 y 7. Resolución de lesiones en vulva en una cerda en 6 semanas.

LEJOS DE CONOCER SU ETIOLOGÍA Y SU CONTROL
Se han descrito en otras especies alteraciones muy similares.
Un ejemplo de ello es el Síndrome de Dermatitis Ulcerosa en perros pastores (Collies y Shetlands), que fenotípicamente es muy similar, con lesiones en la unión dermoepidérmica , aunque se caracteriza por un infiltrado linfocitario. Además, se observa gran cantidad de leucocitos y cristales en orina, con afectación renal.
También existen cuadros clínicos similares en en el ser humano:
El Penfigoide Gestacional, una patología autoinmune que se manifiesta en el segundo y tercer tercio de la gestación en mujeres, cursando con un prurito intenso.
La Dermatitis Autoinmune por Progesterona que desencadena una reacción de hipersensibilidad en mujeres durante su ciclo menstrual debido a las fluctuaciones de esta hormona.
Lo que sí está más o menos claro es la relación que tiene el PUDS con la gestación de las cerdas, quizá debido a cambios hormonales o a hitos del desarrollo del embrión y de la propia gestación.
También se han descrito alteraciones autoinmunes que no responden a tratamientos con corticoides a menos que se empleen dosis extremadamente altas, muy por encima de las recomendadas. Y todo esto, entre otros muchos factores, está aún por estudiar.
Los casos son muy aislados y, a priori, no parecen afectar al comportamiento del animal ni es contagiosa.
Todo ello hace muy difícil su seguimiento, la obtención de muestras y la posibilidad de profundizar en su investigación. Sin embargo, es un campo abierto a quien pueda aportar el más mínimo avance en este sentido.
ACCEDER A BIBLIOGRAFÍA

Síndrome de dermatitis ulcerativa en cerdas: ¿te suena? DESCÁRGALO EN PDF
HERIDAS BAJO CONTROL
PROTEGE LA PIEL, PROTEGE TU PRODUCCIÓN

bioseguridad desde la piel
Cicatrizante fisiológico para animales de producción
Acelera la cicatrización
Previene infecciones secundarias
Forma una película protectora transpirable e impermeable a contaminantes
Aplicación fácil y segura
Su fórmula avanzada
Crea una barrera protectora duradera
Favorece la regeneración tisular













STREPTOCOCCUS SUIS: CLAVES DIAGNÓSTICAS DESDE LA LESIÓN HASTA EL LABORATORIO
Amália Ferronato, Manoela Marchezan Piva, Ângela Rocio Poveda Parra y Aline de Marco Viott
Universidade Federal do Paraná (UFPR) – setor Palotina, Brasil
Streptococcus suis es una bacteria comensal del tracto respiratorio superior de los cerdos que, en los últimos años, ha causado importantes pérdidas económicas en toda la cadena de producción porcina brasileña, europea y norteamericana.
La infección clínica se presenta principalmente en lechones durante las fases de cría y maternidad, y ocasionalmente en cerdos de engorde.


Diversos factores de riesgo pueden predisponer a los cerdos a la infección, al debilitar sus barreras inmunitarias y generar condiciones propicias para la proliferación de la bacteria.
Como consecuencia, se desarrolla una enfermedad inflamatoria sistémica que, por lo general, se caracteriza por:
Meningoencefalitis
Poliartritis
Poliserositis fibrinosupurativa
Neumonía intersticial
Endocarditis valvular


debe basarse en la asociación entre las lesiones anatomopatológicas y el aislamiento bacteriano de los tejidos afectados.
Tras el aislamiento, la confirmación y el serotipado pueden realizarse mediante PCR.
PRINCIPALES SIGNOS CLÍNICOS
En las fases iniciales de la infección por S. suis, los animales presentan signos específicos como apatía, fiebre, pelaje áspero e hiperemia cutánea (Imagen 1).
A medida que la enfermedad avanza, se observan signos clínicos locomotores, como inflamación articular, cojera y resistencia al movimiento.
Pueden aparecer signos neurológicos como decúbito lateral, opistótonos, movimientos de pedaleo, convulsiones y nistagmo.

Al tratarse de una enfermedad inflamatoria sistémica, pueden verse afectados tanto la serosa como el endocardio, y algunos animales pueden presentar dificultades respiratorias asociadas a neumonía, pleuritis y endocarditis.
La mortalidad suele producirse durante las fases aguda y subaguda de la infección.
Algunos lechones pueden morir a causa de un shock séptico hiperagudo, mientras que otros pueden desarrollar una plexocoroiditis crónica que desemboque en hidrocefalia.
En estos casos, los signos clínicos difieren y se caracterizan por incoordinación, desorientación y ataxia.

Imagen 1. Cerdo de recría con estreptococia. Presenta signos clínicos de hiperemia y necrosis en la punta de las orejas y la cola, así como signos neurológicos como decúbito lateral, opistótonos e hiperestesia en las extremidades pélvicas y torácicas.

HALLAZGOS MACROSCÓPICOS Y MICROSCÓPICOS
Durante la necropsia, se observan lesiones externas principalmente en los casos de septicemia, caracterizadas por hiperemia y necrosis cutánea, especialmente en las extremidades, como el hocico, las orejas y la cola.
S. suis afecta principalmente a órganos internos, como el sistema nervioso central, las articulaciones, el corazón, los pulmones, el bazo, el hígado y la serosa.

A nivel macroscópico, se suele observar meningitis fibrinosupurativa caracterizada por la acumulación de un exudado inflamatorio opaco, de color blanco amarillento, en la superficie del encéfalo (Imagen 2).
Imagen 2. Cerebro de cerdo con meningitis fibrinosupurativa. Se observa una opacidad difusa en la superficie encefálica, con una discreta deposición de material blanquecino e irregular (fibrina), localizada principalmente en el cerebelo. También se aprecia hiperemia, con vasos meníngeos visibles y un leve enrojecimiento de la corteza.



Dado su contacto con el parénquima nervioso, la inflamación tiende a propagarse, originando encefalitis, plexocoroiditis (Imagen 4) y ventriculitis.
Imagen 4. Cerebro de cerdo con plexocoroiditis fibrinosupurativa. Corte transversal del encéfalo con deposición de exudado purulento en el plexo coroideo de los ventrículos laterales y del tercer ventrículo.
Desde el punto de vista histológico, esta lesión se caracteriza por un infiltrado inflamatorio predominantemente neutrofílico, asociado a la deposición de fibrina que expande el espacio submeníngeo (meningitis fibrinosupurativa) (Imagen 3).
Imagen 3. Cerebro de cerdo con meningoencefalitis fibrinosupurativa. Corte histológico de la corteza cerebral que muestra un intenso infiltrado inflamatorio neutrofílico asociado a fibrina en el espacio meníngeo. También se observa trombosis vascular multifocal (Tinción H&E, objetivo 4x).



En algunos casos, pueden observarse grupos de cocos de S. suis invadiendo la pared de los vasos sanguíneos y el tejido nervioso adyacente, como se evidencia mediante la tinción histoquímica de Gram (Brown-Brenn) (Imagen 5).
Imagen 5. Cerebro de cerdo con meningoencefalitis causada por S. suis. Se observan cocos y diplococos grampositivos en la adventicia de un vaso sanguíneo (Tinción Brown-Brenn, objetivo 100x).


Imagen 6. Cerebro de cerdo con hiperemia difusa y microhemorragias. Superficie encefálica intensamente enrojecida, con presencia de vasos leptomeníngeos visibles y hemorragias multifocales.
Algunos animales pueden presentar únicamente un enrojecimiento difuso del encéfalo, con presencia de vasos meníngeos visibles y manchas hemorrágicas, lo que corresponde a un cuadro de hiperemia (Imagen 6).
La lesión más frecuente suele ser la artritis fibrinosupurativa (Imagen 7).
El análisis histopatológico suele revelar una infiltración de neutrófilos asociada a la deposición de fibrina en la membrana sinovial (Imagen 8).
A medida que la artritis progresa, se identifican distintos estadios del proceso inflamatorio —agudo, subagudo y crónico—, lo que conlleva un cambio en el perfil inflamatorio tisular, pasando de ser predominantemente mononuclear conforme la lesión se cronifica.
Imagen 7. Articulación de cerdo con artritis fibrinosupurativa y edema periarticular. Se aprecia una acumulación de líquido turbio y fibrina en la superficie articular, así como un edema intenso en el tejido muscular adyacente.


Imagen 8. Articulación de cerdo con artritis fibrinosupurativa difusa moderada. Se observa infiltración de neutrófilos y fibrina en la membrana sinovial, así como extravasación hacia la cavidad articular (Tinción H&E, objetivo 5x).

¡LA ÓPTIMA COMPLEMENTARIEDAD!
ADENIA VALENS
LA CERDA EQUILIBRADA

Lechones de alta calidad: peso y homogeneidad al nacimiento
EL MÁS

GRASA DORSAL < 6.3mm
Unos machos elegidos para sus calidades de canal y su rendimiento para todas las oportunidades
Descendientes con alto potencial de crecimiento y de IC
Calidad de canal con buena clasificación al matadero
GMD > 1 100 Un excelente crecimiento
IC < 2.09
Un macho rentable con uno de los costes alimenticios más bajos del mercado



Se observan con frecuencia procesos inflamatorios supurativos y fibrinosos que afectan a la serosa, como pleuritis (Imagen 9), pericarditis (Imagen 10) y peritonitis (Imagen 11).
La serosa tiene la función de recubrir las superficies de los órganos ubicados en las cavidades corporales y, desde el punto de vista histológico, la inflamación se caracteriza por la acumulación de infiltrado neutrofílico y fibrina. A medida que el proceso inflamatorio se cronifica, se produce una proliferación de tejido fibroso y la formación de adherencias cavitarias, lo que compromete la función de los órganos afectados.

Imagen 10. Pericardio de cerdo con pericarditis fibrinosupurativa, cerdo. El pericardio parietal aparece distendido debido a la acumulación de material fibrinoso y purulento.


Imagen 9. Pleura de cerdo con pleuritis fibrinosa. Se observa fibrina adherida a la superficie de la pleura pulmonar. Además, se asocia con neumonía intersticial.

Imagen 11. Peritoneo de cerdo con peritonitis fibrinosa. Se observa fibrina adherida a la serosa del intestino, el bazo y el hígado.
diagnóstico
Debido a la bacteriemia presente, los émbolos cargados de bacterias pueden desprenderse y alojarse en las válvulas cardiacas, especialmente en la válvula auriculoventricular izquierda, pudiendo observarse casos de endocarditis (Imagen 12).
Es posible encontrar casos de neumonía intersticial con edema interlobular (Imagen 13).
El patrón intersticial observado en estos casos puede explicarse por la naturaleza septicémica de la estreptococia, que provoca la liberación intravascular de exotoxinas bacterianas y citocinas inflamatorias, lo que da lugar a una inflamación sistémica y a edema por aumento de la permeabilidad vascular.



Imagen 12. Corazón (endocardio) de cerdo con endocarditis valvular fibrinosupurativa. Se observa un émbolo de fibrina y tejido necrótico adherido a la válvula auriculoventricular izquierda.

Imagen 13. Pulmón de cerdo (muerte natural) con neumonía intersticial y microhemorragias. El parénquima pulmonar se presenta edematoso, sin colapso, y con múltiples áreas hemorrágicas.


Imagen 14. Bazo de cerdo con esplenomegalia. Se aprecia un agrandamiento moderado del bazo, mientras que los demás órganos no presentan lesiones evidentes.
Como consecuencia de la septicemia causada por S. suis, se puede observar un agrandamiento de órganos como el bazo, los ganglios linfáticos y el hígado.
En la necropsia, muchos casos hiperagudos presentan la esplenomegalia como único hallazgo macroscópico relevante (Imagen 14).
Desde el punto de vista histológico, en los órganos linfoides puede observarse una afluencia de neutrófilos, que son drenados a través de las vías linfáticas y, con frecuencia, se acompañan de fibrina.
La presencia de neutrófilos en los sinusoides del parénquima hepático es indicativa de septicemia.
DÓNDE TOMAR MUESTRAS PARA UN DIAGNÓSTICO EFICAZ DE S. SUIS
El aislamiento de S. suis es fundamental para confirmar el diagnóstico de la enfermedad, ya que permite realizar la serotipificación, el antibiograma y determinar la Concentración Mínima Inhibitoria (CMI), herramientas clave para orientar el tratamiento de las manadas afectadas.
Sin embargo, no existe un consenso general sobre cuáles son los puntos de muestreo más adecuados.

Se puede estandarizar la recolección de muestras para el aislamiento bacteriano a partir de los siguientes órganos y tejidos: meninges, líquido cefalorraquídeo (cuando es viable sin contaminación sanguínea), articulaciones, hígado, bazo, inflamaciones pleurales, pericárdicas y peritoneales (cuando están presentes), así como endocardio en casos de endocarditis.
Tras su incubación en agar sangre de oveja al 5 % a 37 °C durante 24-48 horas, las colonias características de S. suis (Imagen 15) se conservan en caldo BHI con un 15 % de glicerol para su posterior análisis por PCR.
Imagen 15. Cultivo de S. suis en agar sangre de oveja al 5 %. Se observan pequeñas colonias alfa-hemolíticas,

Los resultados del aislamiento pueden verse afectados por el estadio clínico del animal.
Es importante tener en cuenta que los cerdos con un curso crónico de la enfermedad no son los más adecuados para la toma de muestras con fines de aislamiento, ya que el agente bacteriano suele estar ausente en las zonas lesionadas.
Hasta el momento, se ha observado que no existe una diferencia estadísticamente significativa en la tasa de aislamiento entre animales tratados y no tratados con antibióticos.
Esto podría deberse al uso excesivo de los antimicrobianos habitualmente empleados frente a las estreptococias, que suelen presentar un perfil de resistencia elevado.

CONSIDERACIONES FINALES
La estreptococia porcina es una enfermedad inflamatoria sistémica, con una elevada mortalidad en los casos agudos y secuelas en sus formas crónicas.
Las principales lesiones observadas son la meningitis fibrinosupurativa, la artritis y la serositis que, con frecuencia, se presentan de forma simultánea, evidenciando así el impacto económico y productivo de la enfermedad.
En lo que respecta al aislamiento bacteriano, las muestras obtenidas de las meninges, las articulaciones y los derrames inflamatorios son las más adecuadas para el diagnóstico de S. suis.
Además, hasta la fecha no se ha evidenciado que el tratamiento antibiótico previo en campo influya en la tasa de aislamiento.
Un conocimiento profundo de la enfermedad es fundamental para implementar medidas preventivas eficaces, como una bioseguridad adecuada, un control riguroso del uso de antimicrobianos y una correcta gestión del ganado, con el objetivo de minimizar las pérdidas económicas y garantizar la salud y el bienestar de los cerdos.
ACCEDER A BIBLIOGRAFÍA

Streptococcus suis: claves diagnósticas desde la lesión hasta el laboratorio
DESCÁRGALO EN PDF

PROYECTO FOTOPUR: SISTEMA INNOVADOR PARA APROVECHAMIENTO FOTOVOLTAICO Y REDUCCIÓN
DE EMISIONES EN BALSAS DE PURINES
Marcos Agudo Vicente Técnico de proyectos I+D+i de Intergia

CONTEXTO AMBIENTAL: IMPACTO DE LA GANADERÍA EN LAS EMISIONES ATMOSFÉRICAS
El principal impacto de la ganadería sobre el medio ambiente son las emisiones de amoníaco (NH3) y las emisiones de Gases de Efecto Invernadero (GEI), como el metano (CH₄) y el óxido nitroso (N20).
De acuerdo con la European Environment Agency (EEA)1 , el sector agrario es causante de casi el 11 % de las emisiones de GEI en la Unión Europea, más del triple que los vuelos internacionales.
Por otro lado, como informa el Programa Nacional de Control de la Contaminación Atmosférica 2023-2030 del Ministerio para la Transición Ecológica (MITECO)2, las actividades agrícolas y ganaderas son responsables del 96% de las emisiones de amoníaco a la atmósfera en España (Figura 1)
Estas emisiones se deben principalmente a la gestión y almacenamiento de estiércoles del ganado y a su aplicación en el campo como fertilizantes.
700
Combustión industrial
Cultivos
Emisiones fugitivas
Ganadería
Generación eléctrica
Otras industrias
energéticas
Procesos industriales
Residencial, comercial e institucional (RCL)
Re no de petróleo
Residuos
Transporte
Uso de productos
Otros
Figura 1. Emisiones de amoníaco por sector agrario (Actualización del Programa Nacional de Control de la Contaminación Atmosférica 2023-2030. MITECO. 2024).
CONTEXTO LEGISLATIVO: EXIGENCIAS
Como respuesta, se han adquirido compromisos europeos en materia de reducción de la contaminación del aire y acción contra el cambio climático que se traducen en estrategias nacionales y legislación específica.
Para el caso de la ganadería española, en el Real Decreto 306/2020, de 11 de febrero se establece que:
Nueva instalación
Las explotaciones existentes con capacidad productiva superior a 120 UGM deberán cubrir la super cie de almacenamiento de estiércoles con técnicas que reduzcan un 40 % las emisiones, respecto a la super cie sin cubrir.
Las explotaciones de ganado porcino de nueva instalación deberán adoptar medidas para reducir al menos el 80 % de las emisiones de NH3 en balsas de purines, respecto a su super cie sin cubrir.
Respecto a la etapa de almacenamiento del purín en balsas, las emisiones de amoníaco aumentan cuanto mayor sea la superficie de contacto entre el purín y la atmósfera (Figura 2). Por ello, las Mejores Técnicas Disponibles sugieren cubrir la superficie de las balsas para evitar la emisión de NH3.
Super cie contacto Tiempo de exposición Barreras físicas
2. Esquema del proceso de la volatilización del amoníaco (NH3). (Adaptado de Snoek et al., 20123).
Figura
CONTEXTO ECONÓMICO: IMPULSO A
LAS
ENERGÍAS RENOVABLES EN EL MEDIO RURAL
En base a criterios tanto medioambientales como económicos, cada vez más explotaciones agrícolas están apostando por las energías renovables.
En el medio rural, la opción más eficiente es instalar un sistema de energía fotovoltaica para autoconsumo.
De esta manera se consigue:
Abaratar costes en la factura eléctrica.
La obtención de energía en caso de explotaciones que se encuentren alejadas de la red nacional.
FOTOPUR: LA EVOLUCIÓN TECNOLÓGICA DE LA FOTOVOLTAICA FLOTANTE APLICADA AL PORCINO
De
la idea a la práctica: primeras pruebas en balsas de purines
Con el objetivo de responder tanto a las necesidades medioambientales y económicas como a las obligaciones legislativas, entre 2020 y 2023 se desarrolló en Aragón el proyecto
“Alternativas en el aprovechamiento y control del potencial de las balsas de purines”, en el marco de las subvenciones de apoyo a acciones de colaboración de agentes del sector agrario.
Se trata de la primera experiencia a nivel mundial que combina la fotovoltaica flotante con balsas de purines (Figura 3), mediante un prototipo instalado en una granja de madres en el municipio de Tauste.
Figura 3. Instalación pionera de fotovoltaica flotante sobre balsa de purines, desarrollada en una granja de madres de Tauste.
Al medir las emisiones y la producción fotovoltaica se alcanzaron resultados positivos:

de reducción de emisiones de amoníaco en la balsa Más del 50%
Hasta un 41%
de ahorro en la factura eléctrica de la granja
Pero también se observaron problemas:
Degradación de algunos materiales metálicos (acero), que sufrieron corrosión por la exposición al ambiente amoniacal.

Se llegó a la conclusión de que, si bien los resultados eran prometedores, resultaban insuficientes, debido a la baja reproducibilidad de los métodos de medición de gases empleados.


Hacia una solución integrada: energía
solar y control de emisiones
A raíz de esta experiencia, algunos de los miembros del proyecto aragonés decidieron continuar explorando esta solución, escalándola a nivel nacional y probándola en distintas tipologías de granjas porcinas.
De esta manera, surge el proyecto FOTOPUR: Sistema de aprovechamiento fotovoltaico y reducción de emisiones de las balsas de purines en granjas porcinas.
FOTOPUR se enmarca en la convocatoria 2023 de ayudas para la ejecución de proyectos de innovación de interés general por grupos operativos de la Asociación Europea para la Innovación en materia de productividad y sostenibilidad agrícolas (AEI-Agri).
El Grupo Operativo, del mismo nombre, que se ha conformado para desarrollar el proyecto está coordinado por la A.D.S. de Porcino Nº1 de Tauste. El resto de miembros son las empresas
Intergia Energía Sostenible, SL y Tauste Centro Gestor de Estiércoles, la Cooperativa del Bajo Duero (Cobadu) y las Universidades de Zaragoza y Politécnica de Cartagena.
El proyecto tiene como finalidad la búsqueda y el desarrollo de soluciones innovadoras y rentables que permitan al sector porcino reducir la emisión de gases perjudiciales, como el amoniaco y el metano, aprovechando la superficie de las balsas de purines para la producción de energía eléctrica proveniente de fuentes renovables.
Sus objetivos son:
Determinar la aplicabilidad de sistemas fotovoltaicos flotantes, tanto existentes en el mercado como diseñados específicamente para balsas de purines.
Medir su impacto en las emisiones contaminantes de las balsas.
Evaluar los impactos sociales, económicos y medioambientales de las soluciones propuestas.
Para ello, se llevarán a cabo dos prototipos demostrativos en los que se cubrirán con sistemas flotantes las balsas de purines de dos granjas de cerdos.
Los primeros pasos del proyecto han sido:
1 2 3 4
Analizar el estado del arte en cuanto a métodos de cubrimiento de balsas de purines e identificar los requerimientos que debe un cumplir un sistema flotante que incorpore fotovoltaica para ser instalado sobre una balsa de purines.
Identificar elementos flotantes existentes en el mercado (para fotovoltaica flotante en concreto y para otras aplicaciones) y estudiar sus características.
A partir de las necesidades del prototipo y de las características de cada sistema, identificar los sistemas más adecuados.

PROTOTIPO 1
Granja de madres en Zamora con sistema comercial
de FV flotante
Uno de los dos prototipos se desarrolla en una granja de 1.400 madres en el término municipal de Calzada de Tera (Zamora).
La granja está conectada a la red eléctrica y ya cuenta con una instalación fotovoltaica para autoconsumo. El nuevo sistema fotovoltaico que forma parte del prototipo se integrará con el existente, aumentando la potencia total y el porcentaje de autoconsumo.
La balsa de purines donde se va a montar el prototipo tiene una superficie de unos 817 m2.
Para cubrir la balsa de purines, se utilizará un sistema fotovoltaico flotante comercial de manufactura española, que ya se emplea habitualmente en balsas de agua, adaptado para su aplicación en balsas de purines para asegurar la máxima superficie de cubrimiento posible (Figura 4).
Se han sustituido todos los elementos de acero por componentes de aluminio, más resistente a la corrosión en ambientes amoniacales. Adicionalmente, se emplearán elementos hexagonales de plástico con lastre para rellenar los huecos entre flotadores que quedan sin cubrir y el resto de la balsa (Figura 5)
En total, el prototipo a instalar tiene una dimensión de 13,5 x 25 m (Figura 6) y cuenta con pasarela de acceso. Para aumentar la seguridad, el perímetro de la isla flotante y la pasarela incorporan barandillas de aluminio.

Figura 4. Esquema del sistema fotovoltaico flotante comercial adaptado para su instalación en balsas de purines, con estructura de aluminio resistente a la corrosión amoniacal.

5. Elementos hexagonales de plástico con lastre utilizados para cubrir los huecos entre flotadores y aumentar la superficie de cubrimiento de la balsa.

6. Vista aérea del diseño del prototipo (13,5 × 25 m) sobre la balsa de purines, incluyendo la isla flotante y la pasarela de acceso.
Figura
Figura
El sistema fotovoltaico cuenta con un total de 56 paneles y una potencia pico de 33,04 kWp.
Con los flotadores se consigue cubrir de manera efectiva en torno al 20% de la balsa, lo que, sumado al cubrimiento proporcionado por los elementos hexagonales, permitirá alcanzar más del 90 % de la superficie.
La producción fotovoltaica esperada es de 50,04 MWh/año y, de ser autoconsumida por la granja en su totalidad, conseguiría ahorrar hasta un 22 % de su factura eléctrica.

PROTOTIPO 2
Granja
de cebo en Tauste con un sistema
innovador
El otro prototipo se desarrolla en una granja de cebo con 6.038 plazas en el término municipal de Tauste (Zaragoza).
La granja está aislada de la red eléctrica y, hasta el momento, obtenía su energía de un generador diésel y de un pequeño sistema fotovoltaico para el movimiento automático de las ventanas.
La balsa de purines donde se va a instalar el prototipo tiene una superficie total de 1.100 m².
Para cubrir la balsa de purines se empleará un sistema artesanal específicamente diseñado para esta aplicación.
El prototipo cuenta con una plataforma modular de muelle flotante conformada por elementos cúbicos de plástico (Figura 7). Sobre esa plataforma se monta una estructura metálica de aluminio (resistente a la corrosión amoniacal) para soporte de los paneles fotovoltaicos inclinados (Figura 8).


Figura 7. Plataforma modular de muelle flotante conformada por elementos cúbicos de plástico.
Figura 8. Estructura metálica de aluminio diseñada para soportar los paneles fotovoltaicos inclinados sobre la plataforma flotante.

La distribución e inclinación de los paneles se ha optimizado para asegurar la eficiencia energética a la vez que la estabilidad estructural del sistema.
En total, el prototipo a instalar tiene una dimensión de 10 x 11 m (Figura 9) y cuenta también con una pasarela de acceso y barandillas perimetrales para aumentar la seguridad.
El sistema fotovoltaico cuenta con un total de 16 paneles y una potencia pico de 9,28 kWp
Con este prototipo se consigue cubrir de manera efectiva un 12 % de la balsa.
La producción fotovoltaica esperada es de 14,90 MWh/año y, de ser autoconsumida por la granja en su totalidad, conseguiría ahorrar hasta un 34 % de su factura eléctrica.

Figura 9. Vista aérea del diseño del prototipo (10 × 11 m) instalado sobre la balsa de purines, incluyendo la isla flotante y la pasarela de acceso.
Los dos prototipos demostrativos se van a instalar a finales de 2025.
Para su montaje se han diseñado unos procedimientos de montaje específicos, teniendo en cuenta las medidas de seguridad necesarias (barandillas de seguridad, EPIs, anclajes, etc.)
Ambos prototipos se han diseñado para soportar adecuadamente el ambiente amoniacal de las balsas y evitar la creación de bolsas de metano. Además, son compatibles con su vaciado y llenado.

PRÓXIMOS PASOS: EVALUACIÓN Y MEDICIÓN
DEL IMPACTO REAL
Una vez instalados los prototipos, comenzarán las mediciones de NH₃ , tanto en la zona cubierta como en un área de control sin cubrir, empleando un protocolo estandarizado mediante cámara dinámica flotante (Figura 10).
En total, se realizarán 24 mediciones puntuales por prototipo durante las estaciones de primavera e invierno.
El análisis de los resultados permitirá identificar el método más eficaz para reducir emisiones, con vistas a llevar la solución al mercado.
Figura 10. Cámara dinámica flotante empleada para la medición estandarizada de emisiones de amoníaco (NH₃) en zonas cubiertas y de control de la balsa.
FOTOPUR busca así aportar al sector porcino una solución eficaz y rentable al problema de las emisiones de amoníaco causadas por los purines.


Proyecto fotopur: sistema innovador para aprovechamiento fotovoltaico y reducción de emisiones en balsas de purines DESCÁRGALO EN PDF
ACCEDER A BIBLIOGRAFÍA
TOLVAS BluHox: ADAPTACIÓN Y EVOLUCIÓN
EN FUNCIÓN DEL
ESTADO
Y FASE DEL ANIMAL

Cuando hablamos de las tolvas
BluHox de Roxell, no hablamos solo de un producto, hablamos de una filosofía de trabajo: adaptarse al ritmo natural del animal, acompañar su crecimiento y hacerlo con la máxima eficiencia.
Durante las últimas semanas hemos instalado dos modelos distintos en dos granjas con realidades muy diferentes:
BluHox 30 Plus
BluHox 145 Plus
Ambos proyectos representan dos fases del mismo camino…
…El inicio sensible del destete y la solidez del engorde.
Dos momentos distintos, un mismo objetivo: precisión, robustez y durabilidad, con las mejores conversiones y en las mejores condiciones.

BluHox 30 PLUS: LA PRECISIÓN Y ADAPTABILIDAD DEL INICIO
El destete es una etapa decisiva. El lechón pasa de la seguridad del nido al reto de adaptarse a una alimentación sólida.
Ahí es donde cada detalle cuenta.
En Almacelles instalamos las tolvas BluHox 30 Plus de destete, pensadas para que esa transición sea más fácil, natural y segura.
Su diseño compacto y accesible crea un entorno cómodo, limpio y atractivo para el animal, favoreciendo que se acerque, explore y aprenda a comer.
El sistema seco-húmedo permite ofrecer pienso y agua de manera simultánea, imitando la forma en que el lechón se alimenta instintivamente. Esto reduce el estrés, mejora la ingesta diaria y disminuye el desperdicio.
El resultado se nota desde los primeros días, adquiriendo animales más tranquilos, más homogéneos y con un crecimiento estable.
En New Farms siempre decimos que “una buena alimentación al principio es la base de un ciclo exitoso” y la tolva BluHox 30 Plus lo demuestra con hechos: menos competencia, más plazas útiles, mejor conversión y un manejo mucho más ágil para el ganadero.
BluHox 145 PLUS: ROBUSTEZ Y DURABILIDAD PARA EL RENDIMIENTO
Cuando el ciclo avanza y los animales crecen, las necesidades cambian. La alimentación ya no solo se mide en gramos, sino en precisión, capacidad y resistencia.
Ahí entra en juego la tolva BluHox 145 Plus, instalada en Els Plans de Sió.
Este modelo está diseñado para la fase de engorde, donde el volumen y la constancia son esenciales.
Su estructura robusta y su sistema de regulación precisa garantizan un flujo de pienso constante, evitando acumulaciones y asegurando que todos los animales tengan acceso simultáneo al alimento.
Pero la eficiencia no es su único punto fuerte, también lo son el bienestar y el acceso fácil al alimento y al agua.
La forma del comedero y la caída del pienso están pensadas para respetar el comportamiento natural del cerdo, minimizando el estrés y las disputas entre animales. Además, la limpieza es rápida y sencilla.

Menos tiempo en el manejo de la tolva significa más tiempo para el control y la observación, lo que se traduce en mejores decisiones.
reportaje

DOS FASES, UN MISMO PROPÓSITO
En ambos proyectos, el enfoque ha sido el mismo:
Ofrecer una alimentación adaptada al comportamiento y las necesidades reales de los animales, sin renunciar a la precisión, robustez, adaptabilidad y durabilidad.
La tolva BluHox 30 Plus optimiza el comienzo y la tolva BluHox 145 Plus, consolida el resultado.
En New Farms valoramos y creemos que el bienestar animal no es una tendencia, sino una condición necesaria para producir con futuro.
Cuando el animal se encuentra cómodo y en equilibrio, todo el sistema funciona mejor. Los lotes son más uniformes, las conversiones mejores y el trabajo diario, más fluido.

NUESTRA FORMA DE TRABAJAR
Detrás de cada proyecto hay algo más que soluciones…
…Hay diálogo, observación y adaptación.
En New Farms acompañamos a nuestros clientes desde el diseño hasta la puesta en marcha, buscando siempre la mejor solución para cada espacio y necesidad.
Cada granja tiene su ritmo, su clima, su forma de trabajar. Por eso, no solo instalamos productos, sino que instalamos sistemas y los adaptamos.
Analizamos cada fase del ciclo, medimos el comportamiento de los animales y adecuamos los parámetros para encajar de forma natural cada proyecto. Además, ofrecemos formación y soporte continuo, porque creemos que el conocimiento compartido es el motor de la innovación.
DESCÁRGALO EN PDF


Tolvas BluHox: Adaptación y evolución en función del estado y fase del animal
BluHox 30
40/70 lechones de 5-45 kg
Desarrollada para mejorar el comportamiento social entre los cerdos y aumentar el consumo de pienso.



BluHox 145

40/70 cerdos de 18-145 kg
Maximiza el crecimiento del cerdo y minimiza el estrés consiguiendo las mejores conversiones.

YAYA WARS: LA CAMPAÑA DE
INTERPORC
QUE UNE TRADICIÓN, EMOCIÓN Y GASTRONOMÍA PARA
CONECTAR A ABUELOS Y NIETOS
En un momento en el que la cocina tradicional vive una renovada valoración entre los consumidores jóvenes, la Organización Interprofesional Agroalimentaria del Porcino de Capa Blanca (INTERPORC) ha lanzado Yaya Wars, un proyecto de branded content que combina emoción, tradición y divulgación culinaria.
La iniciativa, desarrollada junto al popular creador gastronómico Peldanyos busca acercar a la Generación Z al valor cultural de la cocina tradicional y a las recetas familiares elaboradas con carne de cerdo de capa blanca. La iniciativa pone el acento en las raíces, la memoria culinaria y los lazos que unen a abuelas y nietos alrededor de los fogones.



UNA PROPUESTA QUE
UNE GENERACIONES
La iniciativa se apoya en una idea universal: las recetas de las abuelas no solo son sabrosas, sino que guardan historias, valores y una identidad culinaria que forma parte del patrimonio familiar y del país. Sobre esta base, INTERPORC ha desarrollado un formato digital pensado para las nuevas generaciones, en especial para la Generación Z, manteniendo intacto el vínculo con el producto protagonista: el cerdo de capa blanca, presente de forma cotidiana en elaboraciones tradicionales como guisos, asados, estofados, sopas o platos de aprovechamiento que han acompañado a miles de hogares españoles.
El proyecto ha involucrado a creadores muy relevantes entre el público joven —Xuso Jones, Darío Eme Hache, Marina Barrial o Juanki—, que han contribuido a proyectar el mensaje hacia audiencias digitales manteniendo la esencia de la cocina de siempre
Tras un casting nacional, tres parejas de abuela y nieto/a fueron seleccionadas para grabar distintos episodios junto a Peldanyos, convirtiéndose en altavoces naturales del vínculo entre tradición y producto. Cada receta presentada pone de manifiesto cómo la carne de cerdo ha sido, histórica y culturalmente, un ingrediente central en la mesa española.
UNA FINAL QUE CELEBRA
LA COCINA DE SIEMPRE
La final de Yaya Wars, ya disponible en el canal de YouTube de Peldanyos, reúne a las tres duplas finalistas de abuelas y nietos que compiten elaborando sus recetas familiares más representativas. En esta última entrega, Peldanyos presenó junto a Masi Rodríguez, conocida por su participación en MasterChef Celebrity, aportando dinamismo y sensibilidad a un episodio cargado de emoción y recuerdos culinarios.
UN HOMENAJE A LA COCINA DE SIEMPRE
Con Yaya Wars, INTERPORC refuerza su compromiso con la divulgación de los valores culturales y sostenibles del sector porcino, al mismo tiempo que reivindica la importancia de preservar las recetas que han pasado de generación en generación.
Las propuestas de las tres parejas —todas elaboradas con carne de cerdo de capa blanca como ingrediente principal— evidencian el peso que este producto ha tenido históricamente en la cocina española. Yaya Wars: la
Alberto Herranz, director general de INTERPORC, subraya que “Yaya Wars nació como una idea para difundir la alimentación sana y tradicional entre los más jóvenes, pero hemos logrado mucho más: es un homenaje a nuestros mayores, a nuestra tradición culinaria y a la transmisión de valores entre generaciones”. Añade además que “nos ha emocionado comprobar que hemos ayudado a conectar a abuelos y nietos a través de algo tan significativo como las recetas de toda la vida”.
campaña de INTERPORC que une tradición, emoción y gastronomía para conectar a abuelos y nietos

LA FUERZA DEL FUTURO
DEL SECTOR PORCINO
Fernando Laguna Arán
Ingeniero Técnico Agrícola y Veterinario

Uno de los indicativos de la fuerza de un sector es que se garantice su continuidad y eso es precisamente lo que, por suerte, está ocurriendo en el sector porcino español.
Nuestros jóvenes, chicos y chicas, han comprendido la importancia que este sector tiene para la economía y para la supervivencia de nuestros pueblos, así como los avances productivos que se aprecian en la forma de trabajar. Por ello, quieren participar con su entusiasmo y sus conocimientos.
Hablamos con tres chicas que representan el relevo generacional en los tres pilares del sector:

El trabajo en granja El control veterinario


La gestión desde las integradoras

EVA LIZAMA, ganadera de porcino y responsable de Administración y Dirección en Lizama Miguel S.L.
¿Cómo llegaste al mundo de la producción porcina?
Mis padres pusieron en marcha la explotación con sus propias manos hace más de 30 años. Salieron del régimen de integración y hoy seguimos al pie del cañón.
La decisión fue fácil porque me habían creado el puesto de trabajo que yo siempre quise: la administración de una empresa.
Enseguida me di cuenta de que no necesitaba irme muy lejos para hacer lo que más me gustaba. De hecho, la clave era volver a casa.
Tanto mi hermano como yo siempre hemos estado presentes en las decisiones que mis padres tomaban. Siempre hemos sabido qué pasaba en la explotación y por qué. Creo que esto ha sido una parte fundamental para que los dos hayamos decidido quedarnos: no ha habido sorpresas.

Sabíamos qué era trabajar de lunes a domingo porque hemos visto a nuestros padres y también que el esfuerzo tiene recompensa. Somos dueños de nuestras decisiones y de sus resultados. Es una manera de vivir por la que merece la pena pelear.
Ellas son...
EVA LIZAMA
LAURA MATAS
PATRICIA MAZANA

¿Cómo ha evolucionado tu visión del sector desde tus inicios?
Muchísimo. Dedicarme a este sector es como vivir en una MasterClass continua, siempre hay cosas nuevas que aprender.
No somos el villano de la película…
El bombardeo mediático contra los sistemas productivos intensivos es incansable (y está muy bien pagado) y, cuando eres ajeno al sector primario, es sencillo que ese mensaje cale.
Desde que salí de casa para estudiar fuera me tocó sacar la cara muchas veces por los ganaderos —mis padres lo eran—, porque la ciudad ignoraba lo que en el medio rural y en nuestras explotaciones pasaba.
Nos encontramos ante el escenario perfecto…
La ciudad ha perdido las raíces por completo y algunas organizaciones están aprovechando esta coyuntura para adoctrinar basándose en argumentos muy alejados de la realidad.
Tenemos que creernos, como población, que la alimentación de calidad y segura es un derecho, no una mercancía.
¿Qué crees que se podría hacer para mejorar la situación del sector porcino?
Profesionalizarlo aún más.
El sector porcino está a la cabeza de la profesionalización, pero tenemos que contar en los colegios que el sector primario ofrece puestos de trabajo y proyectos de vida viables y gratificantes.
Debemos crear proyectos educativos ligados al sector primario y promocionarlos. Hasta el momento, si no lo has tenido en casa, es prácticamente invisible.
Pero no podemos hacerlo solos. Necesitamos que la administración trabaje, de una vez por todas, en ese reto demográfico que devuelva población a los núcleos rurales (aunque hasta ahora parezca que estén poniendo empeño en todo lo contrario).
¿Cómo recomendarías este sector a otros profesionales?

A una persona a la que quisiera recomendarle este sector le diría que no existe otra profesión con más futuro que producir alimentos y, desde luego, pocas tan satisfactorias como poder decir que estamos produciendo alimentos:
Sanos y seguros.
De alta calidad.
Que cumplen con los mayores estándares de bienestar animal y de calidad y seguridad alimentarias del mundo.

LAURA MATAS, veterinaria de porcino en ARS ALENDI, S.A.
¿Cómo llegaste al mundo de la producción porcina?
Desde que tengo memoria he estado vinculada al sector porcino porque mi familia siempre se ha dedicado a la ganadería y a la agricultura. Crecí en un pequeño pueblo de Cuenca, donde mi familia tiene la granja, y desde niña he vivido muy de cerca ese ambiente.
Mi abuela siempre cuenta que, prácticamente desde que aprendí a hablar, yo ya decía que quería ser “veterinaria de cerdos”. Y la verdad es que es cierto.
Recuerdo acompañar a mi padre los fines de semana a la granja, recorrer las instalaciones con él y, sobre todo, la primera vez que estuve presente en un parto, una experiencia que me marcó mucho.
Mi vocación, en realidad, no creo que tenga mérito propio, es fruto de lo que he visto en casa y del ejemplo de mi abuelo, mis tíos y mi padre.
Ellos me transmitieron la pasión por los animales y el orgullo de trabajar en algo que, aunque exige esfuerzo y sacrificio, resulta muy gratificante. Cuando disfrutas de lo que haces, te esfuerzas todavía más por conseguirlo, y creo que eso es lo que me pasó a mí.

¿Cómo ha evolucionado tu visión del sector desde tus inicios?
Mi percepción del sector porcino no ha cambiado demasiado, porque desde pequeña ya lo conocía de cerca y mi visión estaba bastante encaminada. Sin embargo, al salir de casa y empezar a trabajar en Aragón, me llevé una sorpresa…
Descubrí la gran importancia que se le da al sector, no solo como motor económico, sino también como generador de empleo y como una actividad socialmente reconocida.
En mi zona, en cambio, la ganadería —y especialmente la producción porcina— está muy demonizada. Dedicarse a este sector rara vez se contempla como una opción de futuro y, en muchas ocasiones, se percibe de manera negativa.
Vivir esta diferencia me hizo reflexionar…
Me di cuenta de que lo que en un lugar se valora y respeta, en otro se rechaza sin conocerlo realmente. Para mí, esto se ha convertido en una motivación personal, porque me anima a pensar que, al igual que ocurre en Aragón, en mi tierra también podría cambiar la percepción del sector con el tiempo.

¿Qué crees que se podría hacer para mejorar la situación del sector porcino?
Siempre he creído en el poder de la comunicación y personas como Gemma Ticó hacen una gran labor en este ámbito.
El sector porcino tiene una gran importancia en España, aunque mucha gente lo desconoce.
Por ejemplo, noticias recientes como los aranceles de China aparecen en los telediarios y muchas personas las ven desde su sofá con indiferencia, sin darse cuenta de que detrás de ello hay un motor clave de la economía española, capaz de generar casi medio millón de empleos directos e indirectos.
Creo que la percepción social podría mejorar si comunicáramos de manera más transparente y atractiva lo que hacemos.
A menudo, existe cierto miedo a ser juzgado o a exponerse, pero mi opinión es que debemos estar muy orgullosos de nuestro trabajo y mostrarlo con naturalidad.
Contar historias sobre cómo producimos de manera responsable, sobre la innovación tecnológica en nuestras granjas o sobre la sostenibilidad de nuestras prácticas puede ayudar a que la gente vea el sector con otros ojos.
Creo que hacer que el sector sea atractivo para los jóvenes es clave.
Mostrar que es un ámbito lleno de oportunidades profesionales, que combina tradición con innovación y que permite desarrollar carreras técnicas, de investigación o de gestión puede ayudar a atraer talento y a generar vocaciones.
La comunicación no solo mejora la percepción social, sino que también puede fortalecer al sector desde dentro, porque cuando la gente entiende y valora lo que hacemos, se genera respeto, orgullo y más interés por sumarse a esta profesión.
¿Cómo recomendarías este sector a otros profesionales?
Durante los veranos, muchos estudiantes de veterinaria vienen a nuestras empresas a hacer prácticas y conocer de cerca el sector porcino como posible salida profesional. Siempre les digo lo mismo: es un sector que ofrece muchísimas oportunidades y perspectivas de desarrollo.
En la ganadería, en general, el papel del veterinario es muy valorado y respetado, y en el ámbito porcino esto se nota especialmente.


Es un trabajo que conlleva responsabilidad y exigencia, pero si te esfuerzas y te involucras, las posibilidades de crecer profesionalmente son enormes. Además, permite encontrar un equilibrio real entre la vida laboral y personal, algo que a veces es más complicado en la clínica, donde hay guardias y turnos nocturnos.
PATRICIA MAZANA, adjunta a Dirección en Mazana Grupo Empresarial, S.L.
¿Cómo llegaste al mundo de la producción porcina?
Se podría decir que llegué nada más nacer. Al tratarse de una empresa familiar, siempre he crecido en un ambiente estrechamente ligado a la producción porcina y lo he vivido en casa día a día.
Desde pequeña tuve la ilusión de continuar con la empresa familiar y dedicarme a ello, así que, tras finalizar mis estudios y adquirir experiencia laboral en otros tipos de empresas de distintos sectores en Barcelona, decidí que era el momento de volver a casa y dedicarme a lo que quería enfocar mi futuro profesional.


El trabajo en granja está muy demandado y, si te gustan los animales, puede ser una opción muy gratificante.
Siempre que hablo con mis ganaderos coinciden en que, cuando disfrutas de tu trabajo, el tiempo pasa volando. Cada día es diferente, siempre hay algo nuevo que aprender o mejorar y eso hace que la rutina nunca sea monótona.
¿Cómo ha evolucionado tu visión del sector desde tus inicios?
Siempre he creído que es un sector con potencial y, desde bien pequeña, sabía que quería dedicarme a él. Pero cuando creces y tienes la oportunidad de conocer y trabajar también en otros sectores, te das cuenta de que este tiene aún más potencial del que podía imaginar.
Una de las cosas que más me ha impactado, una vez dentro del sector, es que ofrece muchísimas oportunidades profesionales para gente joven, en empresas que se han consolidado y que son de futuro.
A veces, desde fuera, puede parecer un sector poco atractivo para la gente joven, pero creo que es una visión totalmente errónea y que se debe, en gran parte, a que seguimos siendo un sector desconocido para la población más joven.
Nunca dudé de que fuera un sector que ofrecía trabajo, pero ahora realmente creo que hay grandes oportunidades para desarrollar una carrera profesional:
Bien remunerada.
Con solvencia.
Con potencial de futuro.
El sector porcino está mucho más desarrollado de lo que la gente puede pensar. Incluso yo misma, que siempre lo he vivido de cerca, me sorprendo al ver lo adelantados que estamos en bienestar animal o medioambiente respecto a otros países.
También me llama la atención lo tecnificado que está a nivel de genética, sanidad o nutrición.
Se revisan los detalles más mínimos para optimizar la producción, porque nuestros números se miran con tres decimales, y eso ocurre en muy pocos sectores.
¿Cómo recomendarías este sector a otros profesionales?
Creo que es un sector que hace las cosas muy bien, pero siempre hay que tener una mentalidad autocrítica para intentar mejorar.
Algo relativamente sencillo y que está en manos de todos los que formamos parte de este sector es darnos a conocer.
Mostrar cómo trabajamos, qué oportunidades ofrecemos y lograr que, desde fuera, se nos valore más como sector entre la población en general.
A veces pensamos que es un sector que se mira mal, pero creo que también se debe al desconocimiento y a que, hasta la fecha, solo nos hemos preocupado de trabajar, pero no de mostrar cómo lo hacemos y cómo ha evolucionado la producción.
En este punto, la gente joven que nos hemos incorporado al sector podemos aportar una visión diferente, más enfocada al público joven, aportando mucho valor en esta labor de comunicación que creo que tenemos pendiente, aunque ya se están empezando a hacer cosas.
Los testimonios de Eva, Laura y Patricia muestran que el relevo generacional en el sector porcino no solo es una realidad, sino también una garantía de futuro.
Ellas representan a una nueva generación que ha crecido dentro del sector o ha llegado a él con la mente abierta y que combina formación, compromiso y una visión más amplia de lo que significa producir alimentos en España.
Queda claro que el sector porcino es dinámico, tecnificado y profundamente profesionalizado. Es un sector que sigue creciendo gracias a la innovación, al rigor técnico y al esfuerzo constante de quienes lo forman.
Pero también es evidente que aún queda camino por recorrer, especialmente en comunicación, divulgación y reconocimiento social.
La población joven juega un papel crucial en este punto, aportando nuevas formas de explicar lo que se hace y de acercar el valor del sector a las personas que no lo conocen de primera mano.
¡Trabajar en el sector porcino es construir futuro! Es apostar por un sector capaz de generar empleo estable, impulsar territorios rurales y garantizar alimentos seguros y de alta calidad. Y, sobre todo, es una profesión que permite sentir orgullo por lo que se hace.
El sector porcino español tiene FUERZA. Y si algo demuestran estas tres jóvenes profesionales es que también tiene futuro.
Un futuro preparado, comprometido y con ganas de seguir creciendo.
La fuerza del futuro del sector porcino DESCÁRGALO EN PDF



Ibai, tu equipo es genial... Pero los porcinos son lo nuestro.














